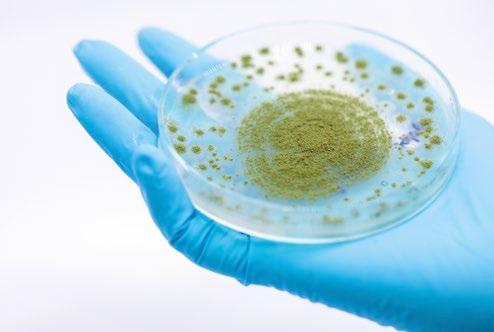

MICOTOXINAS EM SUÍNOS: IMPACTOS ZOOTÉCNICOS E
ABORDAGENS DE CONTROLE











NUTRIÇÃO ANIMAL: QUANDO EFICIÊNCIA PRODUTIVA
SE TRANSFORMA EM SUSTENTABILIDADE REAL
A produção de proteína animal no Brasil alcançou um patamar de liderança mundial que se sustenta na eficiência, na ciência e no investimento em nutrição de qualidade. Cada ganho em conversão alimentar, cada ponto de eficiência no uso de grãos e cada avanço na gestão de resíduos representam não apenas economia, mas sustentabilidade na sua forma mais concreta.
Quando falamos em sustentabilidade, muitas vezes o debate público se perde em slogans ou acusações sem fundamento. A realidade é que nada é mais sustentável do que produzir mais com menos: o frango ou o suíno que chega ao consumidor vem de sistemas altamente controlados, onde a nutrição é planejada de forma precisa para garantir bem-estar animal, eficiência produtiva e segurança alimentar.
O Brasil tem uma matriz energética predominantemente renovável e vem avançando na utilização de biomassa e biocombustíveis a partir dos resíduos da produção. O conceito de economia circular já é realidade em diversas unidades, transformando subprodutos em energia e reduzindo a pegada de carbono. Segundo estudos recentes validados pela Embrapa, o modelo brasileiro de produção agrícola e pecuária permite que as safras se complementem, consumindo carbono de forma recíproca e tornando o processo cada vez mais sustentável.
Outro ponto que precisa ser melhor comunicado é a dimensão da preservação ambiental. Mais de 65% do território brasileiro está protegido, e cada propriedade produtiva mantém, por lei, uma parcela de área preservada. Essa combinação de eficiência no uso dos recursos e compromisso com a preservação coloca o Brasil em posição única no mundo, mas seguimos falhando em mostrar isso de forma clara e acessível.
O mundo se aproxima dos 8 bilhões de habitantes, e metade dessa população está em regiões que ainda não têm segurança alimentar plena. A nutrição animal será determinante para garantir proteína de qualidade e acessível a todos, e o Brasil tem condições de ser protagonista nessa missão. Para isso, precisamos enfrentar gargalos logísticos, superar distorções tributárias e estruturar políticas públicas que fortaleçam a competitividade de toda a cadeia.
Cada fórmula nutricional desenvolvida, cada inovação em aditivos, cada ajuste de manejo dentro das granjas é parte dessa história. Sustentabilidade não é discurso: está no dia a dia da produção, na ciência aplicada, no compromisso com eficiência e no trabalho de milhares de profissionais que fazem da nutrição a base da produção animal.

O desafio, daqui para frente, é comunicar melhor essa realidade. Mostrar que a eficiência produtiva é também a maior expressão de sustentabilidade. Valorizar a ciência e a tecnologia que estão por trás do prato de comida que chega à mesa. E assumir o papel de protagonistas dessa narrativa, com o mesmo orgulho e responsabilidade que já temos em produzir.
José Antonio Ribas Jr. Diretor Técnico nutriNews Brasil

EDITOR AGRINEWS
PUBLICIDADE
Simone Dias +55 11 98585-2436 nutribr@grupoagrinews.com
DIREÇÃO TÉCNICA
José Antônio Ribas Jr.
COORDENAÇÃO TÉCNICA E REDAÇÃO
Tainara C. Euzébio Dornelas redacao@grupoagrinews.com
ANALISTA TÉCNICO
Camila Leandro Ferreira
COLABORADORES
Alex Maiorka
Édina de Fátima Aguiar
Eliane Gasparino
José Luis Repetto
Juliane K. Baron
Keila Mileski Ponte
Lorenna Nicole A. Santos
Magali Soares S. Pozza
Ricardo Souza Vasconcellos
ADMINISTRAÇÃO
Priscila Beck
Contato: +55 15 99682-2274 priscila@agrinewsgroup.com www.nutrinews.com
Avenida: Avenida Adalgisa Colombo, 135 Jacarépaguá. Rio de Janeiro – RJ Cep.: 22775-026
ISSN 2965-3371
A revista nutriNews Brasil é uma publicação nacional, editada em português, cujo editorial é direcionado à nutrição animal, incluindo nutricionistas, fábricas de ração e alimentos para animais, instituições de ensino, sindicatos, empresas e o Ministério da Agricultura e Pecuária. Os artigos, bem como informes publicitários não expressam a opinião dos editores. É proibida a divulgação total ou parcial de conteúdos publicados sem a autorização dos editores.
Preço da subscrição:
USD 30,00 (Brasil)
USD 90,00 (Internacional) Revista Trimestral

CONTEÚDOS
Édina de Fátima Aguiar
Doutora em zootecnia e assessora na iniciativa MIRA
Utilização de fibra dietética e de aditivo estimbiótico na alimentação de fêmeas suínas em lactação e seus efeitos na progênie



Alexandre Barbosa de Brito, Miliane Alves da Costa, Ingrid Martinez
AB Vista LATAM
Nutrição de frangos de corte em sistemas caipiras 10 14 22
Produtividade e saúde animal: os fitoativos são o próximo passo na evolução da produção?
Gabriela Miotto Galli, Bruno Giorgio de Oliveira Cécere, Marcelo Masson Rodrigues¹ e Diko Becker²
¹Equipe técnica-comercial TECPHY
²CEO TECPHY
Qualidade de ovos de galinhas Rhodes Island Red, criadas em sistema livre de gaiola e suplementadas com blend de óleos essenciais, ácidos orgânicos, curcumina e taninos: uma alternativa promissora para a produção sustentável
Keila Mileski Pontes¹, Angélica de Souza Khatlab² e Eliane Gasparino³
¹Doutoranda em Produção Animal, Universidade Estadual de Maringá
²Doutora em Produção Animal, Universidade Estadual de Maringá
³Professora do Curso de Zootecnia da Universidade
Estadual de Maringá
SAMITEC consolida nova fase com foco em inovação analítica e saúde animal
Equipe técnica SAMITEC
Dicas nutricionais práticas para controlar o estresse térmico e manter o desempenho das aves

para rações (IFP)
Equipe Técnica Phosphea
Equipe técnica ARM & HAMMER
Micotoxinas em suínos: impactos zootécnicos e abordagens de controle
Juliane K. Baron1,2, Anne Caroline Araújo1,2, Maria Letícia B. Mariani1,2, Camila C. Prestes¹, David Erd¹, Alex Maiorka1,2, Simone Gisele de Oliveira1,2 ¹Universidade Federal do Paraná; Programa de pós-graduação em zootecnia
Efeito da suplementação com PEPTASANTM sobre o desempenho e a saúde intestinal de frangos desafiados com Eimeria Spp.
Equipe técnica NUPROXA
Nutrição de bezerras: pontos-chave para garantir o sucesso da futura leiteira 56
Efeitos de BACILLUS SPP. na modulação da microbiota intestinal de gatos
Lorenna Nicole Araújo
Santos, Isabela Cubateli
Bogo, Ricardo Souza
Vasconcellos, Magali
Soares dos Santos Pozza Universidade Estadual de Maringá (UEM)
José Luis Repetto, Germán Antúnez e Cecília Cajarville Departamento de Produção Animal e Saúde nos Sistemas Produtivos. Faculdade de Veterinária, Universidade da República.
Navegando no labirinto das micotoxinas com o MYCO’KINGDOM
Equipe técnica OLMIX







NUTRIÇÃO DE FRANGOS DE CORTE EM SISTEMAS CAIPIRAS
Édina de Fátima Aguiar
Doutora em zootecnia e assessora na Iniciativa MIRA

Há uma busca crescente de consumidores por produtos com características diferenciadas e que preservem o bem-estar animal.
Nessa direção, observamos o aumento de sistemas alternativos para a criação de frangos de corte, como é o caso dos frangos caipiras.

Este tipo de sistema tem influência sobre as condições diferenciadas do produto final, como as características organolépticas e físico-químicas, sendo o tipo de textura, coloração e sabor.
Além disso, as aves mantidas no sistema caipira têm acesso ao ambiente externo, com a presença de forragens e luz natural, no qual podem expressar seus comportamentos naturais.
Os frangos caipiras têm a oportunidade de estarem inseridos em um ambiente mais próximo do seu habitat natural, favorecendo o desenvolvimento de sua massa muscular, redução de gordura, e manter os animais mais ativos, apresentando desta forma, menos problemas de pernas e com maior possibilidade de lidar com situações de estresse.

A produção de frangos de corte em sistemas do tipo caipira também tem como princípio a preocupação com o bem-estar animal, pois este modelo de sistema está vinculado à manutenção da sanidade animal.
Muitos estudos indicam que animais submetidos a situações de desconforto, privações e estresse tornam-se mais propensos a doenças, comprometendo não apenas seu bem-estar geral, mas também aumentando os custos da produção.
O setor de produção de aves caipiras apresenta uma série de mitos a serem esclarecidos, pois devido as aves apresentarem a característica de rusticidade, isso conduz ao pensamento errôneo de que elas não necessitam de cuidados durante o período de produção.
A nutrição destas aves, por exemplo, é de extrema importância, pois suas exigências nutricionais variam de acordo com o sexo, linhagem, consumo e disponibilidade de nutrientes nos alimentos.
Sendo assim, é importante que esses frangos tenham acesso a uma dieta balanceada que possa suprir suas necessidades estruturais, produtivas, além de auxiliar na capacidade de absorção de nutrientes, permitindo que a ave tenha suas condições de bem-estar atendidas e que possa expressar todo seu potencial produtivo.
Nutrição de frangos

É importante considerar que as aves mantidas no sistema de criação do tipo caipira, possuem características próprias e apresentam curvas e taxas de crescimento diferente das linhagens convencionais, tendo assim, um crescimento mais lento, o que faz com que suas exigências nutricionais possam divergir das exigências de frangos de corte convencionais.
Com isso, a alimentação representa um custo de produção em torno de 70%, pois essas aves podem consumir até 30% a mais de alimento, pelo fato destas aves também terem acesso ao ambiente externo.
Portanto, a fim de minimizar custos elevados na alimentação destes frangos e continuar fornecendo uma alimentação de qualidade, prudente de fontes de alimentos alternativos.
Uma alimentação para as aves, que somente seja baseada em alimentos alternativos, sem formulação que atenda às suas necessidades energéticas, pode causar problemas de saúde e diminuir o desempenho das aves.
Por outro lado, é possível também o uso de resíduos agrícolas, como a parte aérea da mandioca (folhas), que normalmente são abandonados no campo, transformando-os em proteína animal.
É necessário considerar que, para a alimentação das aves, as plantas precisam ter elevado valor nutritivo, baixo teor de fibra e alta digestibilidade.
Mesmo quando alimentadas com plantas de elevada qualidade, os frangos caipiras, em razão das suas exigências nutricionais, necessitam de

Energia necessária para cada fase de produção
Carboidratos
Lipídios
Proteínas
Vitaminas
Minerais
Os principais ingredientes na formulação de rações para aves são o milho e o farelo de soja. Entretanto, vários produtos podem substituir, parcialmente, estes dois ingredientes como o sorgo, o milheto, o farelo de mandioca, o farelo de batata doce, entre outros.
É importante ressaltar que essa substituição deve ser feita com cautela, pois dessa forma, não irá alterar os níveis energéticos e protéicos das rações para que não haja diminuição significativa na produção e saúde das aves.
Outro ponto importante é o acesso das aves caipiras aos piquetes, que podem complementar essa alimentação com porções mais tenras das plantas, que são ricas em nutrientes e mais nutritivas, incluindo ainda alguns frutos como manga, acerola, caju, entre outros ou restos de colheita e culturas.

O valor nutricional varia entre diferentes plantas e são dependentes da fertilidade do solo. Em uma mesma planta, o teor de fibra irá depender da parte considerada (folhas, ramos e frutos) e da sua idade.
De fato, dada a grande diversidade de itens que podem ser fornecidos às aves caipiras, contribuindo para seu bem-estar e expressão dos seus comportamentos naturais, além da economia de ração balanceada, reduzindo os custos de produção.
A criação de frangos caipiras é uma atividade produtiva, que tem apresentado altos índices de crescimento em função do tipo de sistema, que possibilita o aumento do grau de bem-estar das aves por meio do fornecimento de um ambiente que lhe garanta conforto e estímulo à expressão comportamental.

Nutrição de frangos de corte em sistemas caipiras BAIXAR EM PDF
Nutrição de frangos

Nas modernas instalações de produção de suínos na América
Latina, identificar as fases críticas e reconhecer todas as estratégias essenciais para melhorar o desempenho dos animais, se torna fundamental.
UTILIZAÇÃO DA FIBRA DIETÉTICA E DE ADITIVO ESTIMBIÓTICO NA ALIMENTAÇÃO DE FÊMEAS SUÍNAS EM LACTAÇÃO E SEUS
EFEITOS NA PROGÊNIE
Alexandre Barbosa de Brito, Miliane Alves da Costa, Ingrid Martinez AB Vista LATAM

De acordo com Bonetti et al. (2021), vários aspectos contribuem de forma importante neste desafio, em especial quando falamos da fase pré e pós desmama dos leitões, sendo fatores relevantes a desmama precoce destes animais, alteração de fatores sociais, mudanças na dieta, alterações morfofuncionais ao longo do trato digestivo e alterações das dietas do estado líquido para um sólido. Estes dados referem-se a uma pressão de incremento de produção de leitões (hiperprolificidade) e à busca por excelentes taxas de conversão alimentar.
Estes fatores podem levar a uma taxa de crescimento reduzida, períodos prolongados de jejum e anorexia pós desmame com graves consequências.


Todas essas circunstâncias interconectadas exercem efeitos prejudiciais sobre a saúde geral dos leitões à desmame, proporcionando o ambiente ideal para o aparecimento de diarreia pós-desmame (PWD), uma das doenças economicamente mais relevantes na suinocultura devido ao custo de terapias, taxas de crescimento mais lento e aumento da mortalidade.

Por muito tempo, o uso de medicamentos veterinários e mesmo de óxido de zinco tem sido amplamente adotado para mitigar estes efeitos de estresse pós desmame.
Mas uma das estratégias que nutricionistas e sanitaristas podem tomar como base para mitigar estes riscos, fundamenta-se no uso de fontes de fibra dietética e de aditivos estimbióticos para transformar o potencial da fibra naturalmente presente no alimento dos leitões (ou mesmo da fêmea suína) em uma fonte potencial de prebiose intestinal, associando-se assim um baixo custo da estratégia para lograrmos um excelente desenvolvimento de um microbioma degradante de fibra, que geralmente é positiva para a saúde intestinal e para a performance do animal.
Para avaliar este efeito na dieta de fêmeas em lactação e igualmente no alimento de leitões pós desmame, uma equipe de pesquisadores da universidade de Illinois e da AB Vista (Acosta et al., 2024) avaliaram os efeitos da xilanase (Econase XT, AB Vista) e de um aditivo estimbiótico (Signis, AB Vista) no desempenho e na digestibilidade de nutrientes de leitões desmamados onde as matrizes também consumiram xilanase ou não na dieta de lactação. As hipóteses avaliadas foram:
a leitegada proveniente de matrizes alimentadas com xilanase na lactação proporciona maior desempenho em leitões pós desmame e;
Xilanase e o Aditivo Estimbiótico melhoram o desempenho e a digestibilidade de energia bruta, bra dietética e energia digestível na dieta para leitões após a desmama.
Para isso, um total de 120 leitões recém desmamados de matrizes alimentados com uma dieta de lactação sem xilanase e 120 leitões de matrizes alimentadas com uma dieta de lactação contendo 16.000 unidades de xilanase (BXU) por kg foram usados.
N
Os leitões foram distribuídos seguindo um fatorial de 2 x 3, sendo dois grupos de matrizes (dieta de lactação sem ou com xilanase) e três tratamentos dietéticos para os leitões após o desmame, ou seja: 1) controle; 2) controle mais 100 g/t de xilanase, e; 3) controle mais 100 g/t de aditivo estimbiótico.

Os leitões foram desmamados em 4 blocos e atribuídos a 12 boxes por bloco, com 5 leitões por box para um total de 8 boxes por tratamento. Os leitões foram alimentados com dietas divididas em 3 fases, sendo: fase 1 de 1 a 14 dias, Fase 2 de 15 a 28 dias e fase 3 de 29 a 42 dias pós desmama.
A desmama foi realizada com leitões aos 21 dias de idade. O ganho médio diário, consumo ração diário e a eficiência alimentar (ganho/consumo) foram calculados. As amostras fecais foram coletadas ao final das fases 2 e 3. Os dados foram analisados por meio do procedimento MIXED do SAS.
O modelo estatístico demonstrou que os leitões desmamados tiveram um melhor (P < 0,05) ganho de peso, eficiência alimentar, coeficiente de digestibilidade energética e de fibra dietética na fase 2 e 3 quando alimentados com a dieta com estimbiótico e xilanase, se comparado com animais do grupo controle.
Quando alimentados com a dieta com estimbiótico e xilanase, se comparado ao grupo controle, os leitões desmamados apresentaram melhor (P < 0,05):
Ganho de peso E ciência alimentar
Coe ciente de digestibilidade energética
Fibra dietética na fase 2 e 3
Em conclusão, os leitões alimentados com dietas contendo xilanase e em especial com aditivos estimbiótico tiveram maior digestibilidade de nutrientes e energética (P<0,05), resultando em maior ganho de peso e eficiência alimentar no período total avaliado (42 dias após desmame), mas a alimentação de matrizes com xilanase na lactação não influenciou o desempenho de crescimento pós-desmame, embora futuras avaliações quanto ao efeito deste aditivo e principalmente do aditivo estimbiótico deva ser avalialiado nesta fase, em especial quanto ao perfil de modulação de microbioma da fêmea e seu impacto na progênie.
Se necessitam de mais detalhes sobre os dados descritos anteriormente, por favor, entrem em contato com um representante de AB Vista, estaremos sempre a sua disposição.
Utilização da fibra dietética e de aditivo estimbiótico na alimentação de fêmeas suínas em lactação seus efeitos na progênie BAIXAR EM PDF
Referências sob consulta junto ao autor

PRODUTIVIDADE E SAÚDE ANIMAL: OS FITOATIVOS SÃO O PRÓXIMO PASSO NA EVOLUÇÃO DA PRODUÇÃO?
Gabriela Miotto Galli, Bruno Giorgio de Oliveira Cécere, Marcelo Masson Rodrigues¹ e Diko Becker² ¹Equipe técnica-comercial TECPHY ²CEO TECPHY

Ouso de aditivos na pecuária constitui uma estratégia amplamente adotada para elevar os níveis de produção de carne e leite, por meio do aprimoramento da fermentação ruminal, da modulação da microbiota, do aumento da digestibilidade dos nutrientes e, consequentemente, da melhoria da qualidade dos produtos finais.
Os antibióticos, utilizados há décadas como promotores de crescimento na produção animal, promovem melhorias no desempenho zootécnico dos animais.
Todavia, existe uma crescente preocupação mundial, especialmente por parte dos consumidores, quanto ao uso indiscriminado desses compostos, devido ao risco de resíduos na carne e no leite, além do potencial de induzir resistência bacteriana (ELGHALID ET AL., 2020).
Nesse cenário, intensificam-se os estudos em alternativas que possam substituir os antibióticos promotores de crescimento, especialmente na linha de aditivos naturais.
Entre esses, destacam-se os óleos essenciais, flavonoides, saponinas, terpenos, taninos e outros compostos bioativos de origem vegetal, resultantes do metabolismo secundário das plantas, que vêm demonstrando efeitos múltiplos e positivos (KHOLIF & OLAFADEHAN, 2021).
Efeitos esses conhecidos como: Imunomoduladores, antioxidantes, moduladores de microbiota, estimulação enzimática e demais condições benéficas que ainda são objetos de estudos. Portanto, se tornam uma ferramenta para otimizar a produção animal de forma sustentável.
Importante ressaltar que o pleno desempenho dos fitoativos depende do equilíbrio entre a dose correta e a sinergia entre os diferentes compostos, fatores que juntos garantem resultados muito mais eficazes e seguros do que o uso de substâncias isoladas ou em quantidades inapropriadas.
Com base nessas condições apresentadas e apostando na sinergia entre os fitoativos, a TECPHY vem desenvolvendo pesquisas a partir da combinação entre carvacrol e timol (advindos do óleo essencial de orégano), cinamaldeído (advindo do óleo essencial de canela), eucaliptol (advindo do óleo essencial de eucalipto) e extratos vegetais.

que terão sua função gradual e pontual no intestino, e parte não microencapsulada, agindo prontamente no rúmen.
Sendo assim, a associação de óleos essenciais e extratos vegetais pode atuar ao longo de todo o trato gastrointestinal, desempenhando funções como a modulação positiva da microbiota, promoção da integridade da mucosa intestinal, e estímulo à atividade enzimática.
Isso pode resultar na redução do estresse oxidativo, estímulo à resposta anti-inflamatória e promoção da saúde e desempenho dos ruminantes.
Anti-in amatório
Macrófago
TNFα iNOS
IL-1β
IL-6
Área relacionada ao S no cérebro
IL-12
Resposta pró-in amatória
Estresse oxidativo Menos oxidantes Mais antioxidantes

RESULTADOS EM RUMINANTES
Este estudo teve como objetivo avaliar o potencial de substituição da monensina (25 mg/kg de concentrado) por uma combinação entre os óleos essenciais de orégano, canela e eucalipto, associados a extratos vegetais, na dose de 1g animal/dia na dieta de bovinos de corte durante as fases de crescimento e terminação.
Observamos que a combinação dos fitoativos resultou em maior peso corporal (+32,2 kg), maior ganho de peso médio diário (GMD) (+15,09%) e maior consumo de matéria seca (MS), além de demonstrar melhor eficiência alimentar (+6,66%) em comparação à monensina sódica ao final do experimento (p ≤ 0.05) (Figuras 1, 2 e 3).
É sabido que a melhora no desempenho zootécnico em ruminantes está associada à saúde ruminal e intestinal, atribuída, em grande parte, às propriedades antioxidantes, antiinflamatórias e imunomoduladoras dos fitoativos.
Destaca-se ainda a importância de uma microbiota equilibrada e eficiente como fator-chave nesse processo.
Figura 1. Peso corporal (PC) de bovinos Angus consumindo fitoativos vs monensina

Figura 2. Ganho de peso diario (GMD) e consumo de materia seca (CMS) de bovinos Angus consumindo fitoativos vs monensina
Ganho de peso kg/dia 33-153 d Consumo de MS (kg/dia)
Figura 3. Eficiência alimentar de bovinos Angus consumindo fitoativos vs monensina
0.10
Fitoativos 33-153 dias
Fitoativos
Além de otimizar o desempenho dos animais, os fitoativos tiveram a capacidade de modular o produto final (carne) de forma benéfica. Observamos uma diminuição numérica na quantidade de ácidos graxos saturados e monoinsaturados, bem como um aumento nos ácidos graxos poli-insaturados (p ≤ 0.05) (Figura 4).
Monensina
Monensina

que consumiram fitoativos vs monensina
Ácidos graxos saturados Ácidos graxos monoinsaturados Ácidos graxos poli-insaturados Ácidos graxos insaturados
Esse resultado sugere que os fitoativos influenciaram o metabolismo lipídico e a atividade da microbiota ruminal, promovendo alterações no perfil de ácidos graxos da carne. Essa modificação pode beneficiar tanto a saúde animal quanto a qualidade nutricional do produto destinado ao consumidor final.
Outra pesquisa foi realizada com objetivo de avaliar o desempenho de bovinos a partir do consumo dos fitoativos fornecidos individualmente na dieta, na dose de 1g animal/dia.
Além disso, o experimento testou a combinação dos fitoativos com promotores de crescimento convencionais (monensina a 333 mg/kg de matéria seca e flavomicina a 29 mg/kg de matéria seca) nas doses de 1 g/ animal/dia e 2 g/animal/dia.
Os resultados indicaram que bovinos alimentados com a combinação de monensina, flavomicina e fitoativos na menor dose apresentaram maior peso corporal final e maior peso de carcaça, além de uma melhor conversão alimentar e maior eficiência alimentar.
Além disso, se compararmos os compostos individualmente, os fitoativos ainda se sobressaíram sobre os promotores de crescimento convencionais (APCs) (Figura 5, 6 e 7).
Figura 5. Peso inicial, peso final e peso de carcaça de bovinos de corte que consumiram fitoativos e sua combinação com APCs
214,3215,8223,0214,7 398,7402,4418,4401,5
6. Conversão alimentar de bovinos de corte que consumiram fitoativos e sua combinação com APCs
Figura 7. Eficiencia alimentar de bovinos de corte que consumiram fitoativos e sua combinação com APCs
Figura 4. Perfil de ácidos graxos na carne de bovinos Angus
Figura
Peso Inicial Peso Final Peso Carcaça

Este fato mostra que os fitoativos além de agirem em sinergia uns com os outros, possuem a capacidade de se combinar com demais compostos e potencializar ainda mais seus efeitos.
Testamos ainda o uso da combinação entre os óleos essenciais de orégano, canela e eucalipto associados a extratos vegetais na produção leiteira. Observamos resultados promissores, principalmente em relação à saúde e ao desempenho produtivo dos animais
O objetivo do estudo foi avaliar a inclusão de 2 g/animal/dia do aditivo em vacas Jersey no pico de produção. Observou-se que os animais tratados apresentaram, em média, um aumento de 1,01 kg de leite/dia ao longo de todo o período experimental (Figura 8).
Além disso, os fitoativos mostraram ação antiinflamatória a partir da diminuição dos glóbulos brancos, o que reflete que os animais não estavam passando por processos inflamatórios, logo não dependiam da mobilização elevada de leucócitos para combater essas condições (Figura 9).
Figura 9. Contagem de leucóticos sanguíneos em vacas que consumiram ou não a combinação dos fitoativos
Fitoativos
Observou-se também efeito imunomodulador, com aumento dos níveis de IgA e IgG de cadeia pesada nos animais que receberam fitoativos (Figura 10 e 11).
Figura 8. Produção de leite diária das vacas que consumiram ou não a combinação dos fitoativos
*P tratamento x dia = 0,05 P dia = 0,01
Dias de experimento
Controle
Fitobiótico
Figura 10. Níveis de IgA sanguíneo em vacas que consumiram ou não a combinação dos fitoativos
p dia: 0,01
p trat x dia: 0,01

Efeitos antioxidantes também foram observados com o consumo dos fitoativos, já que os animais que receberam o aditivo apresentaram níveis reduzidos de espécies reativas de oxigênio (ROS) e de substâncias reativas ao ácido tiobarbitúrico (TBARS) em comparação ao grupo controle, em determinados momentos do experimento (Figuras 12 e 13).
Figura 11. Níveis de IgG de cadeia pesada sanguíneo em vacas que consumiram ou não a combinação dos fitoativos
p dia: 0,01
p trat x dia: 0,01
p dia: 0,01 p trat x dia: 0,01 1,4 1,2
Figura 12. Níveis de espécies reativas ao oxigênio sanguíneo em vacas que consumiram ou não a combinação dos fitoativos
p dia: 0,03 p trat x dia: 0,05
Figura 13. Níveis de substâncias reativas ao ácido tiobarbitúrico sanguíneo em vacas que consumiram ou não a combinação dos fitoativos

fitoativos contribuíram para a neutralização de radicais livres e a prevenção de danos celulares relacionados ao estresse oxidativo.
Controle Fitoativos
Todos os resultados supracitados, nos levam a crer da capacidade que a combinação perfeita dos compostos, associado à tecnologia aplicada aos fitoativos, tem a capacidade de agir tanto de forma fisiológica, quanto metabólica no organismo dos animais promovendo saúde e desempenho de forma natural e eficiente.
CONCLUSÃO
O potencial dos fitoativos é amplo e respaldado por evidências que demonstram sua atuação como antioxidantes, antiinflamatórias, imunomoduladoras e moduladoras da microbiota.
Assim, os fitoativos surgem como uma possível alternativa eficaz e segura para promover a saúde dos animais, maximizar a produtividade e atender à crescente demanda por uma pecuária mais sustentável e responsável.
Produtividade e saúde animal: Os fitoativos são o próximo passo na evolução da produção?
BAIXAR EM PDF


“Como CEO da Tecphy, meu principal sonho é que nossas soluções tecnológicas para a indústria de produção animal sejam benéficas à saúde humana.”
Ciência, natureza e inovação para transformar a produção animal
Inovação com propósito
• Aplicação da ciência em aditivos naturais.
• Redução no uso de antibióticos e anticoccidianos.
Posicionamento estratégico
• Posicionar a TECPHY entre as principais empresas do setor.
• Produtos próprios, reconhecidos por sua eficácia e respaldo técnico.
Compromisso com a sustentabilidade
• Impacto positivo no meio ambiente e na sociedade.

Tecnologia Alemã

Dr. Diko Becker CEO Tecphy
Cultura de excelência
• Valorização dos colaboradores.
• Parceria com centro de pesquisas.

QUALIDADE DE OVOS DE GALINHAS
RHODES ISLAND RED, CRIADAS EM SISTEMA LIVRE DE GAIOLA E SUPLEMENTADAS COM BLEND DE ÓLEOS ESSENCIAIS, ÁCIDOS ORGÂNICOS, CURCUMINA E TANINOS:
UMA ALTERNATIVA PROMISSORA PARA A PRODUÇÃO
SUSTENTÁVEL
Keila Mileski Pontes1, Angélica de Souza Khatlab2 e Eliane Gasparino3 1Doutoranda em Produção Animal, Universidade Estadual de Maringá 2Doutora em Produção Animal, Universidade Estadual de Maringá 3Professora do Curso de Zootecnia da Universidade Estadual de Maringá
Nos últimos anos, a cadeia produtiva de galinhas poedeiras vem sofrendo uma constante pressão pública, relacionada ao bem-estar dessas aves.
A tendência é que a produção de galinhas poedeiras em gaiolas convencionais, a mais utilizada atualmente, seja gradualmente substituída por outros modelos de criação.
Entre os modelos de criação que podem ser usados alternativamente as criações tradicionais que fazem uso de gaiolas, está o cage-free, sistema em que as aves são criadas soltas dentro de galpões, com acesso a cama, ninhos e poleiros e o free-range, onde, além de soltas nos galpões, as aves podem circular ao ar livre ao menos em parte do dia.


Esses sistemas alternativos de criação visam principalmente o bem-estar das aves, bem como a oportunidade de as mesmas realizarem seus comportamentos naturais como empoleirar-se e ciscar (da Silva et al., 2006; Chai et al., 2019; Bist et al., 2023).
Além disso, nestes modelos de criação, também é observado que existe melhora da resistência óssea e da condição dos pés das aves (Ledvinka et al., 2012).
Todos estes fatores, independente do sistema de criação, podem levar à alteração da qualidade do ovo (Lara-Bueno, 2023), ao aumento da porcentagem de ovos sujos e/ou rachados, e colocados fora do ninho (Ledvinka et al., 2012).


Apesar dos benefícios, os sistemas alternativos de criação assim como os convencionais também apresentam desafios na manutenção do bem estar das aves, isso porque as galinhas poedeiras são frequentemente expostas a agentes estressores, sejam estes de origem nutricional (por exemplo, a rancificação e ou a presença de micotoxinas na ração), origem ambiental (calor e frio extremos), origem infecciosa (infecção causada por microrganismos e ou parasitas) e por fim, fatores fisiológicos, como a alta taxa de produção e a idade avançada da ave (Lara-Bueno, 2023)

Ainda em aves criadas em ambientes livres de gaiola, o maior contato com microrganismos e poeira, quando comparados ao sistema tradicional, pode aumentar o risco de doenças infecciosas, parasitoses e contaminação dos ovos (Arruda Leite et al., 2024).
A utilização de antibióticos é outro ponto de pressão enfrentado por essa cadeia de produção. Por muitos anos, os antibióticos foram utilizados em doses baixas nos sistemas de produção animal, ficando conhecidos popularmente como melhoradores de desempenho, como uma estratégia para a mitigação dos fatores relacionados aos desafios de criação.
Entretanto, devido ao risco de resistência bacteriana tanto do animal como do ser humano, a cada dia a lista de fármacos proibidos aumenta (Bosetti et al., 2020). Contudo, a retirada dos antibióticos sem um produto substituto pode levar a grandes desafios.
Neste contexto, o manejo nutricional é um fator essencial para a produção animal e a adição de aditivos fitoterápicos na alimentação das aves é uma das alternativas mais promissoras atualmente, uma vez que esses aditivos apresentam mecanismos de ação semelhantes aos dos antibióticos e com a vantagem de ser natural e não causar resistência bacteriana.
Nutrição
Dentre os aditivos utilizados, estão aqueles que são compostos por uma combinação de óleos essenciais, ácidos orgânicos, curcumina, taninos, vitaminas, microminerais, entre outras substâncias naturais, que são conhecidos por seus efeitos antibacterianos, anti-inflamatórios e antioxidantes.
Esses aditivos atuam de forma benéfica no organismo animal auxiliando na manutenção da saúde intestinal das aves, na melhoria da imunidade, na redução do dano celular e no aumento da eficiência produtiva (Abd El-Hack et al., 2022).
Sabendo que a nutrição materna interfere diretamente nos nutrientes depositados no ovo (Videla et al., 2020) e que isso pode influenciar diretamente a qualidade dos ovos e dos pintainhos, diversos estudos têm sido conduzidos para verificar a eficiência do uso de aditivos fitoterápicos, vitaminas e minerais na ração das galinhas poedeiras (Ding et al., 2017; Liu et al., 2020; Feng et al., 2021).
Estudos demonstraram que dietas de galinhas poedeiras com aditivos naturais podem auxiliar a saúde geral das aves além de fornecer proteção aos lipídios da gema contra a oxidação, mantendo a qualidade do ovo por mais tempo, um ponto chave tanto para ovos incubáveis como para a durabilidade dos ovos na prateleira (Calder, 2015; Migliorini et al. 2019).
A manipulação da ração das galinhas pode ainda influenciar a composição de lipídeos da gema, o que é importante para a saúde humana (Calder 2015).
O efeito da dieta de galinhas poedeiras na composição lipídica dos ovos, em especial visando o aumento dos ácidos graxos poli-insaturados, os chamados PUFAs, conhecidos especialmente pelos seus efeitos cardioprotetores (Dedousi et al., 2022) e a diminuição do teor de ácidos graxos saturados, famosos pela associação com a incidência de doenças do coração (Dal-Bosco et al., 2024) é um exemplo dessa manipulação alimentar.
O ovo é, portanto, uma fonte encapsulada de macro e micronutrientes, prontos para sustentar o desenvolvimento embrionário até a eclosão, mas, também, uma fonte de nutrientes de alta digestibilidade e preço acessível, sendo um alimento básico para os seres humanos (Réhault-Godbert et al., 2019).
O estudo de aditivos de origem natural, como substitutos para os antibióticos na avicultura atuam como uma alternativa promissora na avicultura, proporcionando uma produção mais sustentável, ao mesmo tempo em que mantém a sua eficiência produtiva.




Através do desenvolvimento de estudos relacionadas ao tema, os pesquisadores buscam, além de aves saudáveis e produtivas de qualidade superior, visando tanto o desenvolvimento embrionário da progênie, no caso de ovos destinados a reprodução, bem como a saúde do consumidor final dos ovos de prateleira (Bastos et al., 2017; Pontes et-al., 2024; Tolomeotti et al., 2024).
O grupo de pesquisa (GeneZ – Universidade Estadual de Maringá) em consonância com as atualizações deste setor, começou em 2021 a investigar os efeitos do blend de óleos essenciais, ácidos orgânicos, curcumina, taninos, vitamina E e zinco na dieta de codornas de postura (Pontes et al., 2024) e em frangos de corte (Tolomeotti et al., 2024).
Recentemente também form avaliados os efeitos desse blend sobre a qualidade dos ovos de galinhas da raça Rhodes Island Red criadas em sistema cage free
Essas aves receberam ração com 1,5 kg/ton do blend microencapsulado composto por óleos essênciais (canela, eugenol, timol, orégano e capsaicina), ácidos orgânicos (ácido cítrico, fumárico, sórbico, málico), curcumina, taninos, vitamina E e zinco.
O experimento foi realizado na Fazenda Experimental de Iguatemi, da Universidade Estadual de Maringá (UEM-FEI). As aves foram alojadas em galinheiros de madeira equipados com ninhos, poleiros, cama de maravalha, comedouros e bebedouros, em ambiente com climatização natural e com livre acesso a água e ração.
O sistema de iluminação utilizado foi o natural e artificial (16 horas/luz/dia). Os tratamentos consistiram em ração basal sem adição do blend (T1), e ração basal suplementada com 1,5 kg/ton de blend (T2).
Após 28 dias de experimento, 25 ovos de cada tratamento foram coletados em dias alternados, durante 15 dias, para avaliar a estabilidade oxidativa, forte indicativo de sua qualidade.
Para isso, nós realizamos as análises que mensuram a capacidade da amostra de eliminar os radicais livres 1,1-difenil-2picrilhidrazil (DPPH) e 2,2'-Azino-bis(3etilbenzotiazol-6-sulfônico) (ABTS·+) e a peroxidação lipídica primária (dienos conjugados).
Como resultado, os ovos oriundos das aves suplementadas com o blend (T2) apresentaram maior estabilidade oxidativa (capacidade de resistir aos processos de oxidação).


Além disso, também foram avaliados a composição de ácidos graxos (AG) da gema e determinados os índices de gordura saudável (IGH), índice de trombogenicidade (TI) e índice de aterogenicidade (AI), que nos fornecem informações importantes não só da qualidade nutricional do alimento, como também, da predisposição do alimento em causar doenças cardiovasculares nos humanos em função da sua composição de ácidos graxos.
Esses índices foram calculados através da proporção de gorduras saturadas (ácido mirístico, palmítico e esteárico), gorduras monossaturadas (ácido oleico, palmitoleico e vacênico) e poliinsaturadas (ácidos linoleico, linolênico e araquidônico) detectadas na gema dos ovos (Dal-Bosco et al., 2024).
Com relação a composição de ácidos graxos da gema, nós observamos que as concentrações de ácidos saturados (mirístico e palmítico) foram significativamente superiores na gema dos ovos das galinhas do grupo T1, enquanto os ácidos graxos poli-insaturados (PUFA) dos tipos ômega-6 (ácido linoleico) e ômega-3 (ácido α-linolênico) apresentaram níveis mais elevados no grupo T2 que recebeu ração com o blend.
Figura 1. Perfil de ácidos graxos na gema dos ovos das matrizes consumindo ração com e sem a adição do blend. Ácido Mirístico: (p = 0,0110); Ácido Palmítico: (p = 0,0009); Ácido Linolênico: p = ( 0,0307); Ácido Linoleico: p = (<.0001);
Em complemento, o grupo suplementado apresentou maior Índice de Gordura Saudável, menor Índice de Aterogenicidade (potencial de contribuição de um alimento para a formação de placas ateroscleróticas nas artérias) e menor Índice de Trombogenicidade (potencial de contribuição para a formação de trombos nos vasos sanguíneos) (Figura 2).
Palmítico Linoleico Oleico Esteárico
Per l de Ácidos Graxos na Gema
Mirístico Palmitoleico Vacenico Linolenico Araquidonico
Controle Com blend
Nutrição avícola














Índice de Gordura Saudável

de Trombogenicidade
Índice de Aterogenicidade
Figura 2. Valor médio dos Índices de Gordura Saudável (IGH), Índices de Trombogenicidade (TI) e Índices de Aterogenicidade (AI) nos ovos do grupo Controle (sem a adição do Blend) e grupo Blend (suplementados com o Blend de óleos essenciais, ácidos orgânicos, curcumina e taninos). IGH: (P = 0,0999%); TI: (P = 0,0066% ); AI: (0,0001%).
Os resultados obtidos neste estudo demonstram que a suplementação da dieta de galinhas poedeiras da raça Rhodes Island Red com um blend microencapsulado de óleos essenciais, ácidos orgânicos, curcumina, taninos, vitamina E e zinco é uma estratégia promissora para a produção de ovos com maior qualidade nutricional e estabilidade oxidativa, especialmente em sistemas de criação cage-free.
A melhoria nos índices de gordura saudável e a redução dos índices de aterogenicidade e trombogenicidade reforçam o potencial desse tipo de suplementação não apenas para a saúde das aves, mas também para o bem-estar humano, ao oferecer um alimento mais funcional e seguro.

Estes achados corroboram a viabilidade de práticas nutricionais mais sustentáveis, alinhadas com as exigências crescentes por bem-estar animal e redução do uso de antibióticos na avicultura moderna.
Embora os mecanismos moleculares e fisiológicos envolvidos no uso de aditivos fitogênicos ainda não estejam completamente elucidados, os princípios ativos utilizados neste estudo apresentam-se como uma alternativa viável, eficiente e ética para a cadeia produtiva de ovos, sejam eles incubáveis ou destinados ao consumo.
Qualidade de ovos de galinhas Rhodes Island Red, criadas em sistema livre BAIXAR EM PDF
Referências sob consulta junto ao autor

SAMITEC CONSOLIDA NOVA FASE COM FOCO EM INOVAÇÃO ANALÍTICA E SAÚDE ANIMAL
Com quase duas décadas de atuação, o SAMITEC amplia capacidades técnicas e renova sua liderança para fortalecer posição como referência em ciência aplicada ao agronegócio.

Referência consolidada em análises de micotoxinas e saúde animal, o SAMITEC –Soluções Analíticas, Microbiológicas e Tecnológicas representa hoje uma das mais completas estruturas de pesquisa aplicada ao agronegócio brasileiro.
Fundada em 2007, a organização construiu uma trajetória de crescimento sustentado, baseada em rigor científico, inovação tecnológica e proximidade com as demandas do setor produtivo.
Trajetória e credibilidade
Ao longo de sua história, o SAMITEC consolidou uma base técnica robusta, aliando excelência operacional a um modelo de gestão orientado pela qualidade.
Já em 2008, apenas um ano após sua criação, implantou seu sistema de gestão da qualidade e obteve a certificação ISO 9001, demonstrando desde cedo sua atenção à eficiência e à confiabilidade dos processos.

Em 2014, ampliou seu reconhecimento técnico com a acreditação ISO/IEC 17025 para ensaios químicos em alimentos e bebidas, com escopo voltado às análises de micotoxinas (CRL 0841), reforçando sua atuação em segurança alimentar.
Com foco contínuo na expansão das capacidades analíticas, o SAMITEC inaugurou, em 2019, a unidade de microbiologia, seguida, em 2020, pela extensão do escopo acreditado para análises microbiológicas.
No mesmo período, investiu em infraestrutura para experimentos com frangos, intensificando sua contribuição para estudos in vivo em saúde animal.

Um progresso expressivo ocorreu em 2021, com a criação da Unidade de Diagnóstico Anatomopatológico
Animal, voltada ao suporte científico das pesquisas em saúde animal.
Essa estrutura passou a complementar o setor de experimentação com diagnósticos histopatológicos precisos, essenciais para investigações relacionadas a aditivos e doenças emergentes, especialmente nas cadeias avícola e suína.
Mais recentemente, o SAMITEC vem direcionando esforços para ampliar sua capacidade de produção de micotoxinas voltadas à experimentação animal, reafirmando seu compromisso com a ciência aplicada e o desenvolvimento de soluções alinhadas às demandas do agronegócio.
“Cada expansão foi planejada para responder a necessidades concretas do mercado, sempre mantendo os mais altos padrões de qualidade”, destaca a atual gestão do SAMITEC.
Diferencial competitivo
Entre os principais atributos que sustentam a atuação do SAMITEC está a proximidade com o cliente e a capacidade de oferecer soluções alinhadas às necessidades específicas de cada demanda.
Mais do que uma prestadora de serviços analíticos, o SAMITEC se posiciona como um parceiro técnico-científico, desenvolvendo respostas sob medida, fundamentadas no rigor metodológico e na aplicabilidade prática.

Com uma estrutura multidisciplinar e integrada — que reúne laboratórios, unidades experimentais e centros de diagnóstico — garante respostas ágeis, prazos competitivos e alto padrão de qualidade em um setor que exige precisão e confiabilidade.
Pesquisa

O compromisso com a inovação é contínuo, com investimentos regulares em projetos de pesquisa e desenvolvimento voltados à saúde animal e à segurança dos alimentos.
Essa dedicação amplia o alcance do SAMITEC junto a empresas que valorizam não apenas resultados técnicos consistentes, mas também suporte qualificado, visão estratégica e impacto direto na cadeia produtiva.
Nova fase da gestão: fortalecimento técnico e liderança
Com uma equipe de gestão consolidada e experiente, o SAMITEC inicia uma nova etapa marcada pela ampliação das competências técnicas e pelo fortalecimento de sua base científica.
A incorporação de Ricardo Hummes Rauber como CEO, com trajetória reconhecida em pesquisa aplicada e interface com a indústria, representa um movimento estratégico para reforçar a atuação em áreas-chave como saúde avícola e suinocultura.
Os demais gestores, Maurício Schneider Oliveira e Leandro Zanini Giacomini, assumem novas funções estratégicas, consolidando a reestruturação da liderança.
Ricardo Hummes Rauber

Médico Veterinário formado pela Universidade Federal de Santa Maria (UFSM), com mestrado em Medicina Veterinária Preventiva pela mesma instituição, doutorado pela Universidade Federal do Rio Grande do Sul (UFRGS) e pós-doutorado pela Universidade Tecnológica Federal do Paraná (UTFPR), todos com ênfase em sanidade avícola.

Também é especialista em Medicina das Aves pela North Carolina State University. Com mais de 20 anos de experiência em sanidade avícola e suinocultura, atuou em pesquisa, coordenação técnica, consultoria e liderança de projetos no setor agroindustrial.
Cofundador do SAMITEC, retorna em 2025 como CEO para reforçar a gestão técnica e estratégica da organização.

Farmacêutico graduado pela Universidade Federal de Santa Maria (UFSM), com mestrado em Ciência e Tecnologia dos Alimentos e doutorado em Ciência Animal com ênfase em controle de qualidade e período de doutoramento na Universidade de Viena (Áustria).
CEO
Maurício Schneider Oliveira
Diretoria de P&D

Compõe a equipe societária da SAMITEC desde 2014 quando assumiu a responsabilidade técnica dos laboratórios da empresa.
Com experiência consolidada ao longo de seus mais de 15 anos de atuação como cientista e consultor, atua implementando e viabilizando metodologias analíticas aplicadas ao controle de qualidade de alimentos destinados a saúde humana e animal nas mais diversas áreas do conhecimento, assume a Diretoria de Pesquisa e Desenvolvimento (P&D) do SAMITEC.
Sua expertise em métodos analíticos contribui para fortalecer a capacidade da organização em desenvolver soluções inovadoras e integradas às necessidades científicas e produtivas do setor agroindustrial.


Sócio
Leandro Zanini
Giacomini

Cofundador do SAMITEC, Médico Veterinário com sólida experiência em saúde animal e gestão técnica, assume a Diretoria de Operações.
Diretoria de Operações
Sua trajetória na organização e conhecimento operacional contribuem diretamente para a excelência dos processos internos e para a entrega de resultados confiáveis e alinhados às exigências do mercado.
Prof. Titular do Departamento de Medicina Veterinária Preventiva (DMVP) da Universidade Federal de Santa Maria (UFSM). Médico Veterinário, especialista em Toxicologia Animal e Mestre em Medicina Veterinária Preventiva pelo DMVP/UFSM.
Doutor em Microbiologia, área de Micotoxicologia pelo Instituto de Ciências Biomédicas da Universidade de São Paulo, SP.
Possui experiência em assistência técnica e clínica de aves e suínos por um período de 4 anos e em micotoxicologia aplicada e laboratorial por um período de 26 anos, bem como docente desde 2006 nos cursos de Medicina Veterinária e Zootecnia da UFSM.
É especializado na implantação e aperfeiçoamento de programas de gerenciamento e controle de micotoxinas em agroindústrias, como também em biosseguridade e doenças de aves do Laboratório Central de Doenças de Patologias Aviárias do DMVP/UFSM.

Pesquisa
Paulo Dilkin


Perspectivas futuras: integração, ciência e inovação contínua
A renovação da liderança representa um marco estratégico, promovendo maior integração entre desenvolvimento científico, tecnologias analíticas e as demandas do agronegócio.
Com uma equipe ampliada e qualificada, o SAMITEC fortalece sua capacidade de responder rapidamente a desafios emergentes e de ampliar sua atuação em pesquisas aplicadas relevantes para a produção animal.
A experiência consolidada aliada à expertise dos novos gestores reforça a base técnica da organização, potencializando a criação de soluções personalizadas e fundamentadas em evidências científicas.
Nesse cenário, o SAMITEC reafirma seu papel como referência em inovação analítica e saúde animal, mantendo o compromisso com a qualidade dos resultados e a geração de valor para seus parceiros.
Como desdobramento de sua atuação estratégica em saúde animal, o SAMITEC projeta a ampliação de linhas experimentais voltadas ao estudo de desafios induzidos por endotoxinas e agentes patogênicos como Clostridium perfringens, com foco no aprofundamento do conhecimento sobre respostas inflamatórias sistêmicas e intestinais.


Soluções Analíticas, Microbiológicas e Tecnológicas


NOSSAS SOLUÇÕES
Análises Micotoxicológicas
Análises Microbiológicas
Análises Nutricionais
Qualidade de Mistura
Anatomopatologia
Experimentos in vivo
Experimentos in vitro










INFORMAÇÃO ADICIONAL
O TIPO DE MICOTOXINA
Inativadores de micotoxinas que protegem os animais dos efeitos deletérios das micotoxinas através de até cinco diferentes mecanismos de ação:
1) ADSORÇÃO: Sequestrando micotoxinas para que sejam excretadas sem serem absorvidas.
2) BIO-INATIVAÇÃO: Alterando as estruturas químicas das micotoxinas para metabólitos menos tóxicos e/ou mais facilmente excretados.
3) REVITALIZAÇÃO DO SISTEMA IMUNE: Protegendo a resposta imune normal que é suprimida pelas micotoxinas.
Eficácia sobre amplo espectro de micotoxinas, polares e não polares, comprovada através de testes in vitro e in vivo . A bentonita (1m588) presente nestes produtos é aprovada na União Europeia como ingrediente adsorvente de micotoxinas.
4) DEFESA ANTIOXIDANTE: Prevenindo os danos celulares através do manejo eficaz do estresse oxidativo causado pelas micotoxinas.
5) PROTEÇÃO DE ORGÃOS: Prevenindo danos e suportanto o funcionamento normal de órgãos sensíveis às micotoxinas.
a Argilas modificadas com alta capacidade de adsorção (bentonita 1m588 e sepiolita); a Levedura inativada e extratos de levedura ( Saccharomyces cerevisae ). 1-3 kg/t
0,5-2,5 kg/t
Unike® a Argilas modificadas com alta capacidade de adsorção (bentonita 1m588 e sepiolita); a Levedura inativada e extratos de levedura ( Saccharomyces cerevisae ); a Antioxidantes celulares.
0,5-2,5 kg/t
Unike Plus® a Argilas modificadas com alta capacidade de adsorção (bentonita 1m588 e sepiolita); a Levedura inativada e extratos de levedura ( Saccharomyces cerevisae ); a Antioxidantes celulares; a Compostos herbais.
INFORMAÇÃO ADICIONAL
SOBRE O TIPO DE MICOTOXINA
ESPECÍFICA
EFICÁCIA
EMPRESA NOME DO PRODUTO COMPOSIÇÃO DOSE
Adsorvente de micotoxinas de amplo espectro e rápida ação registrado no MAPA, com eficácia comprovada a campo e mais de 20 anos de respaldo científico.
Múltiplas micotoxinas tais como Aflatoxinas, Zearalenona, DON, Ocratoxina A, T2 e Fumonisina.
MYCOSORB® A+ a Parede celular de levedura a Levedura inativada a Aluminossilicato de cálcio e sódio a Farinha de alga Chlorella vulgaris 0,5 a 2 kg por tonelada de ração para animais de produção, aves, aquacultura e animais de estimação.
Fórmula pronta para ser usada em fábricas de rações e granjas. Observe que devido às diferenças de exigências de registro, a descrição dos ingredientes pode ser um pouco diferente entre os países. Contate o representante local para mais informações.
a BOVINOS DE LEITE: 8 gr/ cabeça por dia a BOVINOS DE CORTE: 10-15 gr/animal por dia a SUÍNOS: Matrizes Suínas: 2 kg/ton Leitões: 2 kg/ton Crescimento e Terminação: 1 kg/ton a AVES: 1 kg/ton Amplo espectro de eficácia contra múltiplas micotoxinas: Aflatoxina, Fumonisina, Ocratoxina, DON, T2 e Zearalenona.
BG-MAX™ Combinação de Carboidratos Refinados Funcionais (RFCs) biologicamente ativos e bentonita.
BG-MAX™ Midds ou

INFORMAÇÃO ADICIONAL
SOBRE O TIPO DE MICOTOXINA
EFICÁCIA ESPECÍFICA
NOME DO PRODUTO COMPOSIÇÃO DOSE
EMPRESA
Adsorvente de micotoxinas altamente eficaz que adsorve as micotoxinas mais perigosas. Atua independentemente dos níveis de pH e proporciona uma ação rápida contra as micotoxinas após a ingestão de ração. É um produto seletivo que não interfere com a absorção de nutrientes essenciais, como vitaminas e aminoácidos e é isento de compostos tóxicos (por exemplo, dioxinas e metais pesados).
Eficácia avaliada com base em estudos toxicocinéticos e biomarcadores de exposição a micotoxinas em diferentes espécies-alvo, de acordo com os regulamentos da EFSA.
Complexo metabólico multiação que atenua os efeitos secundários das micotoxinas como a alteração da integridade intestinal, stress oxidativo e alterações dos órgãos-alvo. A administração contínua melhora os parâmetros produtivos e melhora a qualidade dos produtos de origem animal (carne, ovo, leite).
Adsorvente de micotoxinas para espécies aquáticas que oferece uma solução completa para enfrentar o desafio da micotoxicose na aquacultura.
Solução anti-micotoxinas para espécies aquáticas altamente sensíveis a micotoxinas e ficotoxinas com triplo modo de ação: adsorção, bioproteção e efeito pós-biótico.
Aflatoxina B1 (AFB1) / Zearalenona (ZEA) / Toxina T-2 / Fumonisina B1 (FB1) / Ocratoxina A (OTA) / Toxinas alcaloides do ergot (AEs).
De 0,5 a 2,5 kg/t de ração, em função do nível de contaminação por micotoxinas.
Bentonitas (1m558; 1m558i) / Argila sepiolítica.
BIŌNTE® QUIMITŌX®
Solução anti-micotoxinas de tripla ação: adsorção/bioproteção/efeito pós-biótico.
Eficaz contra: a Aflatoxinas (AFB1, AFB2, AFG1 e AFG2), Fumonisinas (FB1, FB2 e FB3), Zearalenona (ZEA), toxinas T-2 e HT-2, Ocratoxina A (OTA), Deoxinivalenol (DON; por desintoxicação) , Toxinas alcalóides do ergot (EAs) a Micotoxinas emergentes (Beauvericina: BEA; Enniatinas: ENN A, ENN A1, ENN B e ENN B1; Esterigmatocistina, ETC) a Micotoxinas modificadas Zearalenona glucuronido (ZEA 14-G).
BIŌNTE® QUIMITŌX® PLUS Bentonitas (1m558; 1m558i) / Argila sepiolítica / Mistura de extratos fitogênicos (extratos de açafrão (cúrcuma) e de cardo mariano)/Parede celular de levedura e levedura hidrolisada. De 1,0 a 2,5 kg/t de ração, em função do nível de contaminação por micotoxinas.
Solução sistêmica que aumenta a viabilidade celular, apresenta atividade antimicrobiana contra Salmonella enterica, Shigella dysenteriae, Staphylococcus aureus e Yersinia enterocolitica ; melhora a qualidade da água e reduz a biodisponibilidade das micotoxinas emergentes no fígado (ácido tenzuanóico).
Solução líquida à base de mistura de extratos fitogênicos (extratos de uva e de azeitona) / Minerais essenciais / Emulsionantes / Conservantes. 1,0 a 2,0 mL/L de água de consumo.
Aflatoxina B1 (AFB1) / Ocratoxina A (OTA) / Zearalenona (ZEA) / Toxina T-2 / Fumonisina B1 (FB1).
De 1,0 a 2,5 kg/t de ração, em função do nível de contaminação por micotoxinas.
Bentonita selecionada (1m558i) / Argila sepiolítica / Aditivo fitogênico para ração animal (farinha de casca de laranja).
BIŌNTE® QUIMITŌX® AQUA

Aflatoxinas / Fumonisinas / Toxinas T-2 y HT-2 / Deoxinivalenol (DON) / Micotoxinas emergentes (Beauvericina, Enniatinas, Esterigmatocistina) / Micotoxinas modificadas.
De 1,0 a 2,5 kg/t de ração, em função do nível de contaminação por micotoxinas.
Bentonita selecionada (1m558i) / Argila sepiolítica / Mistura de extratos fitogênicos (extratos de açafrão (cúrcuma) e cardomariano) e emulsionante / Parede celular de levedura e levedura hidrolisada.
BIŌNTE® QUIMITŌX® AQUA PLUS
INFORMAÇÃO ADICIONAL
Adsorvente e detoxificante de amplo espectro, eficaz contra micotoxinas e outras endotoxinas com efeito depurativo. Pode atuar como agente hepatoprotetor.
EFICÁCIA ESPECÍFICA SOBRE O TIPO DE MICOTOXINA
EMPRESA NOME DO PRODUTO COMPOSIÇÃO DOSE
Fintox Pro Advance a Argilas selecionadas a Leveduras e suas partes a Botânicos a Betaína 1-2 kg/t de alimento em função do grau de contaminação. a Aflatoxinas a ZEA a T-2 a OTA a FB1 a DON a Citrinina a Fumitoxina

INFORMAÇÃO ADICIONAL
EFICÁCIA ESPECÍFICA SOBRE O TIPO DE MICOTOXINA
Principais vantagens do Free-Tox® XP: a Eficaz em baixa dosagem a Alta capacidade de adsorção, tanto em níveis baixos como altos de contaminação a Não adsorve nutrientes a A adsorção permanece estável durante o trato digestivo a Resistente a altas temperaturas a Estimula a saúde do fígado
Free-Tox® XP é um adsorvente de micotoxinas de amplo espectro, altamente eficaz em baixa dosagem contra: a Aflatoxina (B1, B2, G1, G2) a Fumonisina (B1, B2) a Zearalenona a Tricotecenos (T-2, DON) a Ocratoxina A
O
EMPRESA NOME DO PRODUTO COMPOSIÇÃO DOSE
Avicultura e suínos: 0,52 kg/ tonelada
Ruminantes: 1530 g/ animal/dia
Free-Tox® XP (Aglutinante de micotoxinas) a Mistura de aluminosilicatos ativados a Derivados de levedura ( Saccharomyces cerevisiae ) a Inibidor de fungos
Principais vantagens do Free-Tox® Protect: a Eficaz em doses baixas a Alta capacidade de adsorção, tanto em níveis baixos como altos de contaminação a Estimula a saúde do fígado a Não adsorve nutrientes a A adsorção permanece estável ao longo do trato digestivo a Resistente a altas temperaturas
Principais vantagens do Endoban®: a Capacidade de redução muito elevada especificamente para endotoxinas a Eficaz em doses baixas a Melhora a eficiência alimentar a Aumenta o ganho de peso e a produção a Protege dos efeitos negativos das endotoxinas
Principais benefícios do Endoban® FT: a Eficaz em doses baixas a Melhora o desempenho e a eficiência alimentar, estimulando um trato gastrointestinal saudável e reduzindo o estresse inflamatório a Alta capacidade de remoção de micotoxinas e endotoxinas a Não adsorve nutrientes a A adsorção permanece estável durante todo o trato digestivo a Resistente a altas temperaturas a Estimula a saúde do fígado
Free-Tox® Protect é um adsorvente de micotoxinas, muito eficaz contra: a Aflatoxina (B1, B2, G1, G2) a Fumonisina (B1, B2) a Zearalenona a Tricotecenos (T-2, DON) a Ocratoxina A
Avicultura e suínos: 13 kg/ tonelada Ruminantes: 2575 g/ animal/dia
Free-Tox® Protect (Adsorvente de micotoxinas) a Aluminosilicatos de sódio e cálcio hidratados a Protetor hepático a Inibidor de fungos
Ruminantes: 1525 g/ animal/dia O EndoBan® tem uma grande capacidade para eliminar e ajudar a desintoxicar os altos níveis de endotoxinas encontrados no trato intestinal de monogástricos, ruminantes e espécies aquáticas, aumentando assim seu rendimento produtivo e seu ganho.
O Endoban® FT combina o melhor dos dois mundos: elimina os riscos de micotoxinas e endotoxinas, removendo-as do trato gastrointestinal antes que possam exercer seus efeitos tóxicos, favorecendo assim o crescimento e o rendimento produtivo.
Avicultura e suínos: 0,52 kg/ tonelada
Endoban® (Redutor de Endotoxina) a Mistura de aluminosilicatos a Mistura de substâncias aromáticas a Algas vermelhas
Avicultura e suínos: 1,53 kg/ tonelada
Ruminantes: 2550 g/ animal/dia
Endoban® FT (Redutor de Toxinas) a Mistura de aluminosilicatos a Derivados de levedura ( Saccharomyces cerevisiae ) a Mistura de substâncias aromáticas a Algas vermelhas a Inibidor de fungos
EFICÁCIA
DOSE
COMPOSIÇÃO
NOME DO PRODUTO
EMPRESA
A combinação do serviço Myco-Marker ™ e da tecnologia Levian® compõem a plataforma RISE®. O serviço Myco-Marker™ permitepela primeira vezmedir o real impacto das micotoxinas na saúde e produtividade e a otimizar a estratégia de mitigação com o detoxificante (Levian®). Levian® tem vários modos de ação, todos os quais foram demostrados in vivo, para ajudar os animais a combater o estresse: a Apoiar o fígado e os rins a Aumentar a detoxificação a Adsorver (mico)toxinas.
Levian® a Mistura de argilas a Levedura a Antioxidantes a Protetores renais e hepático a SUÍNOS: 12 Kg/t de ração a AVES: 0,75 Kg/t de ração a BOVINOS | ANIMAIS RUMINANTES: 2040 g/ animal/dia Excelente eficácia demonstrada in vivo para todas as principais micotoxinas: a Deoxinivalenol a Aflatoxinas a Fumonisinas a Zearalenona -T-2 a Ocratoxina A a Ergot a Micotoxinas emergentes
Myco-Marker™ , a primeira ferramenta de biomonitoramento por sangue do setor, transforma a ciência de ponta em aplicações práticas, oferecendo diagnósticos superiores e tomadas de decisão informadas. O sangue é coletado por meio de cartões FTA para facilitar o processo de amostragem nas fazendas, sendo necessária apenas uma gota de sangue por animal.
A verdadeira referência no biomonitoramento de micotoxinas. A ameaça de 36 micotoxinas reveladas com apenas 1 gota de sangue.
A silimarina atua como um poderoso hepatoprotetor e o selênio orgânico atua como antioxidante natural.
Myco-Marker ™
AFLA +++ ZEA +++ OTA ++ DON + FUM +
Misturar homogeneamente na ração total, de 0,5 a 2,5 kg/ ton de ração, dependendo da contaminação. Aplicação na fábrica de ração.
FIX HP a Beta-glucanos a Manano-oligossacarídeos a Bentonita a Carvão vegetal ativo a Selênio a Silimarina
Protege de forma eficaz a barreira intestinal e o sistema imunológico dos animais contra a ação das micotoxinas, melhorando a saúde animal e a rentabilidade da fazenda.
Misturar homogeneamente na ração total, de 0,5 a 2,5 kg/ ton de ração, dependendo da contaminação. Aplicação na fábrica de ração. AFLA +++ ZEA +++ OTA +++ DON +++ FUM +++
MT.X+ a Montmorilonita a Tecnologia Algoclay® a Terra diatomácea a Paredes celulares de leveduras a Extratos de algas

Aditivo prebiótico e adsorvente de aflatoxina, fumonisina e zearalenona para produtos para alimentação animal.
SafWall® Parede Celular de Levedura De acordo com o nível de contaminação da ração, ou conforme recomendação técnica. Estudos demonstram a eficácia do SafWall® na melhoria da saúde intestinal, do desempenho zootécnico e na redução dos efeitos negativos causados por micotoxinas em diversas espécies animais.
INFORMAÇÃO ADICIONAL
Produto natural, à base de aluminossilicato hidratado cálcico-sódico (argilomineral não metálico).
Aditivo mineral de uso animal com tecnologia aprimorada, proporcionando maior segurança alimentar.
SOBRE O TIPO DE MICOTOXINA
Produto mineral 100% natural, composto por aluminossilicato hidratado cálcico-sódico. Umidade: 10 a 14% Granulometria: máx. 15% retido em peneira 200 mesh. Adicionar na formulação de rações ou alimentos na dosagem de 2 a 5 kg/ton (0,2 a 0,5%), conforme os níveis de contaminação por aflatoxinas. Atua na adsorção de ampla gama de micotoxinas, com alta afinidade para aflatoxinas.
BIOBOND AFLA
Produto mineral não metálico, composto por mescla de bentonitas modificadas quimicamente (argilominerais).
Umidade: máx. 14% Densidade: máx. 0,9 g/cm³ Granulometria: máx. 15% retido em peneira 200 mesh. Aplicar na proporção de 1 a 2,5 kg/ton de ração, em qualquer fase da produção. Aditivo adsorvente com eficácia comprovada para fumonisinas e aflatoxinas.
BIOBOND FX
Produto natural, à base de aluminossilicato, especialmente indicado para ruminantes.
Aditivo indicado para ruminantes, com capacidade de adsorção de micotoxinas de origem vegetal.
Recomenda-se o uso de 30 g/animal/dia. Estudos demonstram redução na excreção láctea de AFM1 em vacas leiteiras.
Produto mineral 100% natural, composto por aluminossilicato.
Umidade: 10 a 14%
BIOBOND RM
Granulometria: máx. 15% retido em peneira 200 mesh.
Alta capacidade de adsorção de micotoxinas e odores. Atua como aglutinante e promotor de consistência fecal. Produto ambientalmente seguro.
Atua na adsorção de aflatoxinas, fumonisinas e zearalenona. Reduz odores fecais, incluindo amônia, e melhora a consistência das fezes.
Recomenda-se o uso de 3,0 a 5,0 kg/ton de dieta, ou conforme orientação técnica específica.
Produto mineral 100% natural, à base de mistura de aluminossilicatos e aluminossilicatos hidratados cálcico-sódicos.
PETBOND MULTI

Umidade: 7 a 12%
Granulometria: máx. 15% retido em peneira 200 mesh.
Contribui para a produtividade animal: a Melhora na produção de ovos, carne e leite a Redução de perdas nutricionais a Redução de problemas reprodutivos (síndrome estrogênica) a Melhora na conversão alimentar e imunidade a Redução na incidência de doenças e mortalidade a Diminuição dos custos de produção
Aditivo antimicotoxinas composto por mesclas de aluminossilicatos naturais e parede celular de leveduras (rico em mananas e β-glucanas). Atua na adsorção das principais micotoxinas e no suporte imunológico.
Aplicar na formulação de rações ou alimentos na proporção de 1 a 2 kg/ton (0,1 a 0,2%), em qualquer fase da produção.
Composto por mistura de minerais inorgânicos não metálicos.
pH: 8,0 a 11,0
BIOBOND AZ
Umidade: 10 a 13%
Densidade: 0,6 a 1,0 g/cm³
Grupo de estratégias para controle de biotoxinas: a ADSORÇÃO: Ação de amplo espectro; Micotoxinas (AFB, ZEA, FUM, DON, ácido ciclopiazônico, citrinina); Endotoxinas e Exotoxinas (LPS, α-toxina); Age rapidamente após a ingestão da ração, sem interação com outros nutrientes. a DEGRADAÇÃO Degrada micotoxinas e seus metabólitos (ex.: ZEA e α-ZOL, ß-ZOL, α-ZAL, ß-ZAL, ZAL). a BIOPROTEÇÃO
Melhora a barreira intestinal impedindo a passagem das micotoxinas, atua na proteção hepática, estimula as defesas naturais e limita o estresse oxidativo. A linha de aditivos adsorventes de micotoxinas da Salus conta com um programa de controle de biotoxinas que contempla os serviços de avaliação e gestão do risco da intoxicação dos animais.
Aluminossilicato de cálcio e sódio, Bacillus Subtilis (CNCM I-4606), Bacillus Subtilis (CNCM I-4607), Bacillus Subtilis (CNCM I-5043), Cloridrato de betaína, Cúrcuma, Extrato de semente de uva, Parede celular de levedura. 1,5 kg de produto por tonelada de ração ou a critério do técnico responsável. Aditivo adsorvente de micotoxinas indicado para suínos (zearalenona e desoxinivalenol) e aves (aflatoxinas, fumonisinas, desoxinivalenol, ácido ciclopiazônico e citrinina).
Multiprotect Up
Adsorve odores e melhora a consistência das fezes. Para uso exclusivo na alimentação de pets. A linha de aditivos adsorventes de micotoxinas da Salus conta com um programa de controle de biotoxinas que contempla os serviços de avaliação e gestão do risco da intoxicação dos animais.
Aditivo adsorvente de micotoxinas indicado para PET (aflatoxinas, fumonisinas e zearalenona).
3 a 5 kg de produto por tonelada de ração ou a critério do técnico responsável.
Aluminossilicato de cálcio e sódio, Zeolita.
PET
Protech

Melhora o desempenho dos animais Alto poder de adsorção de fumonisinas Alta fluidez, facilidade e uniformidade de mistura Não complexa nutrientes da dieta A linha de aditivos adsorventes de micotoxinas da Salus conta com um programa de controle de biotoxinas que contempla os serviços de avaliação e gestão do risco da intoxicação dos animais.
Aditivo adsorvente de micotoxinas para uso exclusivo na alimentação de bovinos. Melhora o desempenho dos animais Alto poder de adsorção de micotoxinas Alta fluidez, facilidade e uniformidade de mistura Não complexa nutrientes da dieta A linha de aditivos adsorventes de micotoxinas da Salus conta com um programa de controle de biotoxinas que contempla os serviços de avaliação e gestão do risco da intoxicação dos animais.
Aditivo adsorvente de micotoxinas indicado para todas as espécies (fumonisinas).
Aluminossilicato de cálcio e sódio. 1 a 2,5 kg de produto por tonelada de ração ou a critério do técnico responsável.
FM
Protech
Aditivo adsorvente de micotoxinas indicado para bovinos (aflatoxinas, fumonisinas, zearalenona e desoxinivalenol).
30 g/animal/dia ou a critério do técnico responsável.
Aluminossilicato de cálcio e sódio.
Protech Multi RM












INFORMAÇÃO ADICIONAL
SOBRE O TIPO DE MICOTOXINA
EFICÁCIA ESPECÍFICA
EMPRESA NOME DO PRODUTO COMPOSIÇÃO DOSE
TOXO®-XL auxilia na mitigação dos efeitos deletérios das micotoxinas sobre a desempenho e saúde de aves, suínos e pets. Sua fórmula exclusiva combina biopolímeros e β-glucanos purificados, que atuam de forma sinérgica no fortalecimento da barreira intestinal e na modulação do sistema imune — ambos frequentemente comprometidos pela presença de micotoxinas. TOXO®-XL não se liga a nutrientes, tornando-o adequado e seguro para uso em rações e pré-misturas.
TOXO® é um aditivo tecnológico para mitigação de micotoxinas da linha Selko, desenvolvido para reduzir os efeitos negativos das micotoxinas em frangos de corte. Sua ação combina um sistema de adsorção eficaz com componentes funcionais que reforçam a integridade da mucosa intestinal, contribuindo para a redução da absorção de micotoxinas e a translocação de patógenos.
TOXO®-MX é um agente sequestrante de micotoxinas baseado em esmectitas puras e ativadas.
TOXO®-MX ajuda os animais de produção a manterem um estado saudável sem comprometer o desempenho produtivo em caso de exposição a micotoxinas. TOXO®-MX não se liga a nutrientes, tornando-o apropriado e seguro para uso em rações e pré-misturas de aves, suínos, pets e bovinos de leite.
Indicado para micotoxinas de baixa e alta polaridade como ZEA e FUMO.
0,5-2 kg por tonelada de ração.
TOXO®-XL contém bentonita (1m558) com alto teor de esmectita ativada e frações específicas de levedura ( Saccharomyces cerevisiae ) ricas em ß-1,3/1,6-glucanos ativados e biopolímeros.
TOXO®-XL
1 -2 kg por tonelada de ração. Indicado para micotoxinas de alta e baixa polaridade, como AFLA e T-2.
TOXO® contém bentonita (1m558) com alto teor de esmectita ativada e frações inativas e específicas de levedura ( Saccharomyces cerevisiae ), ricas em biopolímeros.
TOXO®
TOXO®-MX contém bentonita (1m558) com elevado teor de esmectita ativada. 12 kg por tonelada de ração. Indicado principalmente para micotoxinas de alta polaridade como AFLA e FUMO.
TOXO®-MX


PARÂMETROS TECNOLÓGICOS DE FOSFATOS INORGÂNICOS PARA RAÇÕES (IFP)
Equipe Técnica Phosphea

Ao analisar um fosfato, é importante levar em consideração 2 tipos de parâmetros:

Parâmetros nutricionais que serão úteis para avaliar a qualidade do produto;
Parâmetros tecnológicos que fornecem informações sobre a estabilidade do produto e, portanto, o risco de reação química.
Este artigo é uma revisão dos parâmetros tecnológicos e suas características que são importantes levar em consideração na formulação de alimentos para animais e na mudança de um fosfato para outro.

GRANULOMETRIA
A granulometria corresponde à determinação das dimensões de um material (partículas / pó / grãos / sólidos partidos) e mais precisamente suas respectivas porcentagens com o estudo da distribuição de tamanho.

A análise granulométrica é, portanto, o conjunto de operações cujo objetivo é determinar a distribuição granulométrica dos elementos que compõem uma amostra. Este método é frequentemente usado na indústria alimentícia, química fina, fabricação de aditivos e indústrias farmacêuticas.
Existem vários métodos para determinar o tamanho das partículas. A escolha entre os diferentes métodos existentes depende do tamanho da partícula.
Enquanto as partículas grandes são medidas manualmente, as partículas > 10 μm de diâmetro são frequentemente medidas por peneiramento e as < 10 μm de diâmetro por difração a laser ou dispersão dinâmica de luz: quando o feixe de laser entra na amostra, as partículas pequenas dispersam a luz amplamente, já as partículas grandes dispersam a luz em pequenos ângulos.

Este método, que utiliza a análise de imagens, é amplamente utilizado porque é reprodutível, confiável e a um custo razoável.
O contador de Coulter é outro método existente que se baseia nas variações da resistência elétrica induzida pelas partículas à medida que passam por um orifício imerso em um eletrólito.
Finalmente, quando não é possível acessar um laboratório ou retirar amostras, pode-se usar o método da sedimentação que consiste na relação entre a velocidade com que as partículas caem em um fluido e o raio das partículas.
A granulometria pode ser realizada por via seca ou úmida. O método seco é usado para caracterizar pós sem destruir a agregação inicial. O método úmido é usado para dispersar as partículas, portanto a análise será realizada em partículas em suspensão.
A granulometria pode afetar outros parâmetros tecnológicos dos fosfatos em rações de animais. Sua uniformidade pode de fato influenciar a homogeneidade do produto final.

A fluidez pode ser influenciada por parâmetros intrínsecos, como teor de água e tamanho de partícula, mas também por parâmetros extrínsecos, como umidade e temperatura.
Os principais métodos existentes para medir a fluidez dos pós são os seguintes: A fluidez, o risco de aglomeração e a reatividade também pode ser afetada pelo tamanho das partículas: os riscos são maiores quando as partículas são menores. As características da produção e das instalações devem ser levadas em consideração na escolha do tamanho mais adequado de partícula.
O método do ângulo de repouso mede o ângulo formado por um pó quando é derramado em uma pilha. Um ângulo menor indica melhor uidez.
Os testes de rosqueamento avaliam a densidade aparente do pó. Um pó que compacta facilmente geralmente tem melhor uidez.
Cada produto da Phosphea possui uma granulometria específica (granular, microgranular ou em pó), cada granulometria correspondendo a uma faixa de tamanhos específica, conforme mostrado na guia abaixo.
Granular
Micro granulado
a 2 mm
a 1.8 mm
Pó 0 a 0.25 mm
FLUIDEZ
A fluidez é a capacidade de um pó fluir livremente de maneira suave e constante na forma de partículas individuais.
Se o pó for "difícil de fluir", pode formar aglomerados que podem danificar o maquinário. O melhor valor de fluidez e, portanto, desejado é 100.
Os estudos reológicos medem a resistência ao uxo do pó sob diferentes condições de tensão e deformação.
As medições de células de cisalhamento avaliam a uidez aplicando uma tensão de cisalhamento ao pó e medindo a força necessária para induzir o movimento. Isso permite uma avaliação quantitativa precisa da uidez.
FRIABILIDADE
A friabilidade é a degradação dos grânulos por ação física (choques mecânicos, fricção). Deve ser o mais baixo possível para que não afete a qualidade do produto.
Se o produto for muito friável, muita poeira será formada nas instalações do cliente, o que pode afetar negativamente a fabricação, embalagem, armazenamento e transporte.
Os produtos devem ser os mais resistentes possível durante todas essas etapas. A fabricação, embalagem, armazenamento e transporte também podem influenciar a friabilidade. É também o caso do teor de umidade, que se for alta, pode levar a uma menor friabilidade.

pH
Os testes de friabilidade são amplamente utilizados na indústria farmacêutica para avaliar a resistência física e a durabilidade de comprimidos e produtos não revestidos.
A ferramenta usada para a medição da friabilidade é chamada de Friabilator ou Testador de Friabilidade. Os testadores de friabilidade usam um método padronizado, reprodutível, confiável e eficaz.
A friabilidade é medida em porcentagem.
O objetivo do Phosphea é ter uma friabilidade abaixo de 1%. Alguns produtos, como o MCP, têm uma friabilidade mais próxima de 0,5%, o que mostra uma boa resistência física do produto.

O pH de um fosfato deve ser levado em consideração de acordo com a espécie em questão e a utilização do produto final. O pH afeta a atividade enzimática e a solubilização de nutrientes no estômago. Os ruminantes têm um pH ruminal básico a neutro (6-7), enquanto os monogástricos têm um pH estomacal ácido (2-3).
Os formuladores de rações para suínos e aves estão, portanto, procurando um fosfato de baixo pH para proteger o intestino de patógenos e promover a solubilização de nutrientes.
Às vezes, eles até usam agentes acidificantes que ajudam a manter o pH ideal no estômago, permitindo um funcionamento correto das enzimas proteolíticas e controlando a microflora intestinal.
No entanto, o pH ácido pode ser corrosivo e, assim, aumentar o risco de desgaste prematuro das máquinas, o que é essencial ter em mente ao mudar de um fosfato básico para um fosfato ácido, especialmente para produtores de ração mineral.
No entanto, os materiais de revestimento são frequentemente usados em linhas de fábricas de ração animal, o que contribui para redução dos efeitos da corrosão.
Cada fosfato inorgânico para rações de Phosphea tem um pH fixo ou faixa de pH específica. O valor de pH mais baixo do IFP da Phosphea é 3 e o valor de pH mais alto é 9,5.
SOLUBILIDADE E REATIVIDADE DO FÓSFORO EM ÁGUA
A solubilidade em água de fósforo (Pse) reflete a proporção de fósforo (P) sob moléculas de MCP que são altamente solúveis em água.
É por isso que um produto MCP tem um Pse acima de 75%, enquanto um MDCP tem um Pse acima de 65% e um DCP, cujo conteúdo de P vem principalmente de moléculas DCP, tem um Pse abaixo de 10%. A quantidade de moléculas MCP de um produto está altamente e positivamente correlacionada com :
SOLUBILIDADE EM ÁCIDO CÍTRICO
A solubilidade em ácido cítrico é um ótimo critério de seleção para um fosfato pois remete o que ocorre no estômago. Portanto a porcentagem de solubilidade do P neste método demonstrará efetivamente a faixa de P do produto que será disponível e será digerida pelo animal
Fosfato de alimentação de alta qualidade
Fosfato de alimentação de baixa qualidade
Rochas fosfáticas
Solubilidade em ácido cítrico a 2%
Coe ciente verdadeiro de absorção (%)
Solubilidade em citrato de amônio alcalino
Fosfatos de boa qualidade possuem solubilidade em ácido cítrico acima de 85%, podendo passar de 95% como o MCP 22,7% da Phosphea, já produtos de baixa qualidade como rochas fosfáticas ou Fosfatos Tricálcicos, dificilmente atingem os 80% podendo até mesmo ficar abaixo dos 50%.
A sua digestibilidade (para as espécies suína, aves e aquáticas)
Sua reatividade
A sua disponibilidade para bactérias ruminais (para vacas)
A reatividade de um produto pode ser medida através do aumento da temperatura em 5 minutos devido à reação entre fosfato e água.
Um produto reativo terá um aumento maior de temperatura (reação exotérmica), o que significa um risco de reação química com outros componentes do premix ou alimento mineral (ex: óxido de magnésio).
Portanto, reatividade baixa a média pode ser buscada para os minerais, premix e blocos minerais, enquanto a uma alta reatividade em ração composta ou loose licks, geralmente não representa um problema.
É por isso que fosfatos como DCP, MDCP, NEOPHOS (fosfato de cálciosódio) ou MAG26 (fosfato de magnésio) podem ser mais adequados para reduzir o risco de reação química com minerais ou vitaminas para produtores de minerais e premix.
Além disso, a reatividade também pode ser influenciada pelo pH.
MCP MDCP DCP
Moléculas TCP Ca3(PO4)2 Menos disponíveis, fezes e urina
Moléculas de DCP CaHP4 Requer acidi cação estomacal
Moléculas MCP Ca(H3PO4), H2O Melhor valorização
>75% >65% <10%
Solubilidade de P em água
ACIDEZ LIVRE E CO2
A acidez livre reflete o conteúdo da molécula H3PO4 no fosfato. O CO2 reflete o conteúdo de moléculas de CaCO3 no fosfato.

A acidez livre e o CO2 são usados para controlar o processo de produção.
A acidez livre pode aumentar os riscos de aglomeração.
METAIS PESADOS EM FOSFATOS
Os fosfatos são fontes essenciais de fósforo e cálcio na nutrição animal, mas podem conter contaminantes naturais como flúor, cádmio, chumbo, arsênio e mercúrio, que comprometem desempenho e segurança alimentar. O flúor é o mais crítico, devendo estar em níveis controlados para evitar fluorose e perdas produtivas.
Seguindo rigorosamente as normativas europeias de segurança alimentar (Regulamento CE nº 574/2011 e posteriores), a Phosphea assegura que seus produtos atendem aos limites estabelecidos, garantindo qualidade, segurança e conformidade regulatória.
Flúor (F) Degeneração óssea 2.000 ppm
Cádmio (Cd) Danos nos rins e no fígado 10 ppm
Chumbo (Pb)
Arsênio (As)
Em ambos os casos, um valor muito alto significa que a reação não está completa: P e Ca não estão totalmente ligados. O risco é maior para fosfatos higroscópicos como o MCP.
Mercúrio (Hg)
Desenvolvimento fetal interrompido Dificuldades sensoriais e de aprendizagem 15 ppm
Deformidades fetais do feto Resistência aos antibióticos 10 ppm
Danos renais e no sistema nervoso central Risco de transmissão para humanos por bioacumulação 0,1 ppm
* Fontes: Regulamento (CE) nº 574/2011 e atualizações da UE sobre contaminantes em matérias-primas para alimentação animal.

ABSORÇÃO DE UMIDADE / UMIDADE
A umidade a 100% corresponde à perda de água livre e não deve exceder 2%. Uma alta umidade aumenta o risco de reações químicas, aglomeração (fluidez reduzida) e armazenamento inadequado.
A perda a 250°C ou 550°C reflete moléculas de água ligadas a moléculas de fosfatos.
O cálculo Perda a 250°C ou 550°C –Umidade a 100°C é usado para saber se um DCP é anidro ou di-hidratado.
Um resultado abaixo de 10% significa que é um DCP anidro, enquanto um resultado igual ou superior a 10% significa que é um DCP di-hidratado que de fato perderá suas moléculas de água ligadas e, consequentemente, mais peso entre 100 °C e 250 °C.
A umidade de um produto final depende do processo de produção (método de secagem), da atmosfera/clima e das condições de armazenamento.
Por que é muito importante sempre analisar a % de umidade e o teor de P juntos?
Quanto maior o teor de umidade, mais fósforo será diluído no produto (para MCP, por exemplo, que são muito higroscópicos).
O teor de umidade pode, portanto, afetar a porcentagem de massa de fósforo no produto, mas a quantidade de fósforo permanecerá sempre a mesma. O teor de umidade também é muito importante ser levado em consideração ao medir os metais pesados de um fosfato: o cálculo deve ser feito a 12% de umidade.
O único regulamento da União Europeia relativo ao teor de humidade dos fosfatos diz respeito à rotulagem: acima de 10% de umidade no produto, deve ser indicado no rótulo.
A Phosphea, empresa do Grupo Roullier, com mais de um milhão de toneladas de capacidade de produção por ano, com 7 plantas em todo o mundo, inclusive uma no sul do Brasil, é líder global na produção de soluções minerais para nutrição animal. Diferenciando-se pela tecnologia, qualidade e vanguarda.
Presente em diversos continentes, destaca-se pela excelência com os mais altos padrões internacionais de sustentabilidade e segurança alimentar, contribuindo para o desenvolvimento responsável da cadeia produtiva em todo o mundo.
Parâmetros tecnológicos de fosfatos inorgânicos para rações (IFP) BAIXAR EM PDF

Empresa Francesa Produção Brasileira




EFEITOS DE BACILLUS SPP. MODULAÇÃO DA MICROBIOTA
INTESTINAL DE
Nicole Araújo Santos, Isabela Cubateli Bogo, Ricardo Souza Vasconcellos, Magali Soares dos Santos Pozza Universidade Estadual de Maringá (UEM)

Probióticos são “Microrganismos vivos que, quando administrados em quantidades adequadas, conferem um benefício à saúde do hospedeiro” (Morelli e Capurso, 2012).
Sua utilização na alimentação animal tem crescido nos últimos anos, devido à maior disponibilidade de cepas comercialmente disponíveis e o melhor conhecimento sobre a sua estabilidade e eficácia em promover a saúde do hospedeiro.
Diversos microrganismos são utilizados atualmente, entre eles bactérias como:
Lactobacillus, Streptococcus, Lactococcus, Bifidobacterium e Enterococcus, além de leveduras e fungos, como a Saccharomyces cerevisiae Aspergillus oryzae


Lorenna
A microbiota intestinal desempenha um papel fundamental na saúde dos animais, contribuindo para a integridade da mucosa e a proteção contra microrganismos patogênicos.

Sua composição pode ser impactada por diversos fatores, como alimentação, idade e condições ambientais, o que pode levar ao desenvolvimento
Esse desequilíbrio é caracterizado por uma menor diversidade bacteriana, diminuição de espécies com potencial benéfico e proliferação de bactérias
Clinicamente, essas alterações estão frequentemente associadas a manifestações como diarreia, reações alérgicas e doenças inflamatórias intestinais (Yang et al., 2023).
Dessa forma, os probióticos agem através de diversos mecanismos no hospedeiro, dentre eles a melhora na barreira intestinal, assim como também na imunidade através do aumento de imunoglobulinas A (IgA) (Wang et al., 2024), além de outros benefícios, como apresentado na figura 1.

1. Exclusão competitiva
Probiótico
2. Produção de substâncias antimicrobianas (AGCC)
3. Melhoria da função da barreia epitelial
4. Imunomodulação
Figura 1: Mecanismos de ação dos probiótico. Adaptado de Latif et al. (2023).
Células T
5. Sinalização sistêmica via sistema nervoso (serotonina, dopamina, GABA)
Em gatos, o uso de probióticos apresenta benefícios tanto em filhotes quanto em adultos, especialmente para a saúde intestinal, ao promover a modulação da microbiota.
Essa modulação favorece as defesas naturais do organismo, estimulando a produção de metabólitos secundários, como os ácidos graxos de cadeia curta (AGCC), além de exercer ação antimicrobiana.
A microbiota intestinal felina é formada principalmente por filos como Firmicutes, Bacteroidetes, Actinobacteria e Proteobacteria (Shi et al., 2024), que fermentam fibras e proteínas, gerando compostos fundamentais para a manutenção da integridade da mucosa e o equilíbrio imunológico.
Um estudo realizado com cepas probióticas de Lactobacillus rhamnosus e Bifidobacterium animalis subsp. lactis, demonstraram boa tolerância à bile, aderência à mucosa intestinal e ação antimicrobiana contra patógenos como E. coli, Salmonella e Clostridioides difficile, além de atenuar a expressão de citocinas inflamatórias em macrófagos (Jang, 2024).

GÊNERO BACILLUS SPP.
As bactérias do gênero Bacillus spp. são classificadas como Gram-positivas, e são caracterizadas como aeróbicas facultativas, heterotróficas, saprofíticas e ubíquas (Arsène et al., 2021).
Apesar de não colonizarem o intestino, podem produzir ácido lático, além de serem resistentes à ação do ácido clorídrico (Kosaza, 1989).
Uma das principais vantagens do uso dessas bactérias em alimentos processados é sua capacidade de formar esporos resistentes, o que garante a viabilidade do microrganismo durante processos industriais rigorosos.
Durante o processo de esporulação, o microrganismo adquire camadas de proteção, que conferem resistência contra agentes físico e químicos, garantindo a proteção do material genético e do metabolismo celular (figura 2) permanecendo dormente, e quando o ambiente se torna favorável ativam novamente metabolismo (Acuff e Aldrich, 2022).
Membrana interna
Receptores germinativos
Interespaço DNA
Exosporo Parede do peptidoglicano da célula germinativa
peptidoglicano
Capa externa proteinacea
Revestimento interno proteico

Figura 2: Esporo de bactérias. Adaptado de Acuff e Aldrich (2022)


A capacidade de esporular é particularmente interessante na fabricação de alimentos para cães e gatos, principalmente pelo processo de extrusão ser a maior parte dos alimentos produzidos.
A combinação de altas temperaturas com alta umidade pode ocasionar a destruição de alguns tipos de microrganismos.
Entretanto, um estudo feito por Okelo et al. (2008), observaram que ao utilizar a espécie Bacillus stearothermophilus durante o processo de extrusão a bactéria foi resistente nas condições de altas temperaturas (77 a 100°C) por período de até 11 segundos com umidade entre 24,5 e 34,5%.
EFEITOS DO GÊNERO BACILLUS SPP.
NA MICROBIOTA INTESTINAL DE GATOS
O uso de Bacillus spp. na nutrição animal já é comum. Estudos antigos já demonstravam a eficácia em animais, como os esporos de Bacillus licheniformis em leitões durante o momento de estresse do período pós desmame, demonstram eficácia na diminuição de diarreias e decréscimo na taxa de mortalidade (Kyriakis et al., 1999).
Nas últimas décadas, a inclusão de Bacillus spp. na alimentação de animais de companhia também obteve crescimento e resultados positivos.
Pesquisas avaliadas em cães suplementados com Bacillus subtilis proporcionaram uma redução na concentração de amônia em adultos, assim como em filhotes foi observado diminuição na diarreia, no odor fecal e nos gases intestinais (Félix et al., 2010; Paap et al., 2016),
como também em estudos recentes, essa espécie demonstrou efeitos sobre a microbiota intestinal, com aumento da diversidade bacteriana, além de propiciar o crescimento de Faecalibacterium, um importante microrganismos produtor de butirato, além de confirmar resultados anteriores, como diminuição da amônia e no odor fecal (Lima et al., 2020).
Assim como em cães, a inclusão de Bacillus spp. na alimentação de gatos também demonstra efeitos promissores, como efeitos positivos sobre o aumento na ingestão, na digestibilidade dos nutrientes, bem como sobre a imunidade e na capacidade antioxidante (Wang et al., 2022), entretanto, os principais resultados são sobre a microbiota intestinal.
Wang et al. (2023) avaliaram um blend de probiótico composto por Bacillus amyloliquefaciens SC06 (BaSC06) e Bacillus subtilis 10 (B10) em gatos saudáveis. Como resultados, foram observados uma diminuição das fezes moles e na taxa de diarreia, assim como houve diminuição em citocinas próinflamatórias (IL- 1β e IL-6) e aumento em anti-inflamatórias (IL-10).
Sobre a microbiota, os pesquisadores encontraram uma clara diferenciação sobre a β-diversidade de microrganismos bacterianos e de fungos, e os animais suplementados com o probiótico, tiveram um aumento do gênero Lactobacillus, o qual podem apresentar benefícios aos hospedeiros (Kang et al., 2022).
Outro gênero encontrado foi o Plectosphaerella, o qual os pesquisadores encontraram associação do microrganismo com o aumento de AGCC, que inclui acético, propiônico e butírico, que agem como antiinflamatório no organismo.
Outra espécie com resultados promissores é o Bacillus clausii. Ruggiero et al. (2025) observaram que o uso desse microrganismo em gatos resultou na melhora do escore fecal, assim como um aumento na concentração de IgA e, diminuição de calprotectina, um marcador proteico aumentado durante processo de inflamação intestinal.
Apesar desse estudo não ter avaliado os efeitos sobre a microbiota fecal, foi detectado um aumento dos AGCC totais, e no butirato.
O aumento dessas substâncias pode ser produzido por bactérias com potencial benéfico, como a Faecalibacterium (Zhou et al., 2018), que por sua vez é considerado um dos microrganismos sentinela do equilíbrio intestinal (Sung et al., 2022).
Os benefícios do Bacillus spp. também se estendem ao tratamento de gatos com diarreia crônica. Lee et al. (2022) ao utilizarem a espécie Bacillus licheniformis, verificaram que o probiótico foi capaz de auxiliar no tratamento da diarreia, assim como proporcionaram aos gatos do grupo tratado um aumento no gênero Blautia spp., uma bactéria produtora de ácido propiônico (Louis e Flint, 2016), bem como uma diminuição da espécie Clostridium perfringens, caracterizada como uma bactéria com potencial patogênico (Brynestad e Granum, 2002).
Entretanto, é importante salientar que nem todas as espécies de Bacillus spp. são seguras para o consumo.
Microbiota

A espécie Bacillus cereus é potencialmente patogênica, devido a produção de toxinas (Anadón et al., 2006), sendo sua ingestão capaz de causar danos graves à saúde e até mesmo a mortalidade (Nikodemusz e Gonda, 1966).
Contudo, o B. cereus var. toyoi não causa danos, sendo inclusive utilizado como probiótico (Anadón et al., 2006).
Em estudos com animais, os probióticos têm sido administrados de diferentes formas, as mais comuns incluem cápsulas e a inserção direta na ração por cobertura superficial (spray coating)
No entanto, a eficácia desses produtos está diretamente relacionada à viabilidade das cepas até o momento do consumo.
Fatores como temperatura, umidade, tempo de armazenamento e o tipo de processamento podem reduzir significativamente a quantidade de microrganismos viáveis, sendo fundamental adotar estratégias tecnológicas que preservem a integridade das cepas (Rodrigues et al., 2020; Vasconcelos, 2018).
CONSIDERAÇÕES FINAIS

Espécies do gênero Bacillus spp. podem apresentar potencial para ser utilizados como probióticos na nutrição de gatos, promovendo benefícios principalmente relacionados à microbiota intestinal.
Ademais, por serem microrganismos esporulados, demonstram alta estabilidade térmica, o que permite sua aplicação em dietas extrusadas sem perda significativa de viabilidade.
Efeitos de Bacillus spp. na modulação da microbiota intestinal de gatos BAIXAR EM PDF
Referências sob consulta junto aos autores
DICAS NUTRICIONAIS PRÁTICAS PARA CONTROLAR O ESTRESSE TÉRMICO E MANTER O DESEMPENHO DAS AVES
Equipe técnica de ARM & HAMMER
As altas temperaturas afetam negativamente o desempenho e os resultados econômicos de granjas avícolas comerciais.

O estresse térmico impacta a saúde intestinal ao prejudicar a função da barreira intestinal, além de aumentar a permeabilidade e inflamação do intestino, alterar a composição da microbiota, reduzir a absorção de nutrientes, o crescimento e desempenho das aves, e aumentar a suscetibilidade a infecções como as causadas por Salmonella e a enterite necrótica.
Durante o estresse térmico, ocorre um menor fluxo sanguíneo para o intestino, o que causa estresse oxidativo e compromete a integridade da mucosa intestinal. Além disso, o estresse térmico suprime o sistema imunológico, incluindo o tecido linfoide associado ao intestino (GALT), o que torna as aves mais vulneráveis a infecções.
Esses efeitos cumulativos levam a uma redução de indicadores de desempenho como ganho de peso corporal, produção de ovos e eclodibilidade.
NUTRIÇÃO


Água:
A água é o nutriente mais crítico para as aves. Ela desempenha um papel fundamental na digestão, transporte de nutrientes, regulação da temperatura corporal e eliminação de excretas, o que impacta tanto a saúde quanto a produtividade.
O fornecimento de água de qualidade – com valores ótimos de pH e sólidos totais dissolvidos (TDS), além de uma baixa contagem microbiana – é essencial para a saúde e desempenho dos animais.
Proteína:
Para melhorar a saúde intestinal e prevenir a disbiose, é importante incluir fontes de proteína altamente digestível na dieta e garantir uma ingestão equilibrada de aminoácidos digestíveis, além de reduzir o incremento calórico e a presença de proteína não digerida no intestino grosso.
Em condições de alta temperatura e umidade, recomenda-se diminuir os níveis de proteína bruta em 0,5-1,0% e aumentar os níveis de aminoácidos digestíveis em 3-5%.
Energia:
É necessário que se tenha um balanço energético efetivo para compensar o menor consumo de ração durante os períodos de estresse térmico. Utilize matériasprimas de baixo incremento calórico, como óleos vegetais e cereais digestíveis.
Além disso, garanta uma relação adequada entre energia metabolizável e lisina digestível para obter um crescimento ideal das aves e evitar a deposição excessiva de gordura.
IMPACTO DO EQUILÍBRIO ELETROLÍTICO DA DIETA (EED)
Um fornecimento balanceado de cátions (íons carregados positivamente – Na+ e K+) e ânions (íons carregados negativamente – Cl-) é necessário para que o equilíbrio ácido-base (EED) das aves seja atingido.
Em condições de altas temperaturas, é essencial que se tenha um EED efetivo (≥240 mEq/kg) para garantir um melhor desempenho e equilíbrio osmótico dos animais.
Sabe-se que altos níveis de sódio (Na) na dieta promovem um maior crescimento das aves, no entanto se esse incremento se der por meio de sais (NaCl) pode-se ter uma maior umidade da cama. Além disso, o potássio (K) é benéfico para aves em situações de estresse térmico.
Portanto, o bicarbonato de sódio e o carbonato de potássio são as melhores opções para manter um EED adequado.
O excesso de respiração ofegante em condições de altas temperaturas leva à alcalose respiratória, o que prejudica o equilíbrio ácido-base do sistema. Portanto, o EED e a escolha dos sais adequados são aspectos importantes em dietas de aves.
DCAD Plus™ é uma forma estável e feed grade de carbonato de potássio produzida pela Arm & Hammer Nutrição Animal que pode ser usada em rações animais para manter o equilíbrio eletrolítico.
ABORDAGEM PRÁTICA PARA O EQUILÍBRIO ELETROLÍTICO DA DIETA
Minimizar os níveis de cloro (Cl) e sulfato (SO4) na dieta.
Primeiro, otimizar a concentração de Na na ração. Juntamente com um conteúdo mínimo de sal, usar NaHCO3 (é melhor que Na nas formas de cloreto ou sulfato) para otimizar o EED. Em seguida, aumentar/equilibrar os níveis de potássio (K) na dieta para atender ao déficit de EED.
Escolher fontes de K livres de cloro ou sulfato. O carbonato de potássio estável (DCAD Plus™) é a melhor escolha para aumentar efetivamente os valores de EED.
Gráfico 1. Alguns dos eletrólitos comumente usados e valores de EED
*Valores de EED calculados pelo peso molecular dividido por 1000
ADITIVOS:
A suplementação de aditivos como enzimas, emulsificantes e ácidos biliares promove uma maior digestibilidade de nutrientes. Recomenda-se aumentar os níveis de minerais e vitaminas (5-15%) na ração, em níveis superiores ao padrão.
CELMANAX™, da Arm & Hammer Nutrição Animal, é um posbiótico que contém Carboidratos Funcionais Refinados (RFCs™) altamente biodisponíveis, uma tecnologia proprietária da Arm & Hammer.
CELMANAX™ é um produto multicomponente desenvolvido para manter a saúde e equilíbrio intestinal dos animais. Ele promove o crescimento de bactérias benéficas e ajuda a manter um ambiente intestinal saudável, além de apoiar o sistema imunológico.
A inclusão de um adsorvente eficaz de toxinas como BG-MAX™ da Arm & Hammer Nutrição Animal na dieta é essencial para neutralizar as micotoxinas, seu impacto negativo nas aves durante períodos de estresse e, também, proteger as células.
O uso de maiores níveis de antioxidantes (vitamina C) na ração, assim como a betaína, ácido butírico, óleos essenciais e acidificantes intestinais, promovem um maior desempenho das aves.
Cepas probióticas benéficas, como CERTILLUS™ da Arm & Hammer Nutrição Animal, melhoram a saúde intestinal e estabelecem uma microbiota equilibrada no trato gastrointestinal.

Soluções microbianas personalizadas e específicas como CERTILLUS™ atuam de modo eficaz contra E. coli patogênica aviária e Clostridium perfringens, enquanto combinações de cepas especializadas apoiam a saúde intestinal e a digestibilidade de nutrientes.
FORMA FÍSICA DA RAÇÃO:
Recomenda-se a utilização de rações trituradas e peletizadas para pintos e frangos de corte durante o verão. No caso de rações
fareladas fornecidas a galinhas poedeiras e matrizes de frangos de corte, deve-se minimizar a porcentagem de pó e garantir uma distribuição de partículas adequada.
Além disso, deve-se manter uma porcentagem de umidade da ração
≥11,0% para consumo.
CONCLUSÃO:
O controle do estresse térmico é uma abordagem holística. Da mesma forma que realizar o manejo da granja e dos galpões, é essencial fornecer uma dieta equilibrada.

O balanço da dieta no que diz respeito à energia, aminoácidos digestíveis, eletrólitos, minerais e vitaminas, assim como a inclusão de aditivos comprovados cientificamente, são fundamentais para combater os efeitos do estresse térmico em aves.
Para saber mais sobre como otimizar o desempenho das aves, visite ahanimalnutrition.com.
Dicas nutricionais práticas para controlar o estresse térmico e manter o desempenho das aves BAIXAR EM PDF


INTRODUÇÃO
MICOTOXINAS EM SUÍNOS: IMPACTOS ZOOTÉCNICOS E ABORDAGENS DE CONTROLE

Juliane Kuka Baron1-a, Anne Caroline Araújo1-a, Maria Letícia Bonadiman Mariani1-a, Camila Castilho Prestes1, David Erd1, Alex Maiorka1-a, Simone Gisele de Oliveira1-a ¹ Universidade Federal do Paraná; aPrograma de pós-graduação em zootecnia
As micotoxinas são substâncias tóxicas produzidas por certos fungos que se desenvolvem principalmente em grãos, como milho, trigo e sorgo, quando expostos à umidade e temperatura inadequadas.
Elas não são visíveis a olho nu e, mesmo em pequenas quantidades, podem causar prejuízos importantes à saúde dos suínos.
As principais toxinas de interesse na suinocultura são produzidas pelos fungos dos gêneros Aspergillus, Fusarium e Penicillium, e entre elas destacam-se as aflatoxinas, zearalenona, ocratoxina, fumonisinas, desoxinivalenol (DON) e os tricotecenos.


Cada uma afeta órgãos e sistemas diferentes, podendo comprometer o fígado, rins, intestino, sistema reprodutivo e imunológico dos animais.
Embora os efeitos mais graves, como morte súbita, sejam raros, a maioria das intoxicações por micotoxinas ocorre de forma crônica e silenciosa.
Isso significa que os animais continuam se alimentando, mas têm pior desempenho, menor ganho de peso, falhas reprodutivas, aumento da incidência de doenças e até necessidade maior de uso de antibióticos.
Essas perdas, muitas vezes, são atribuídas a falhas de manejo ou nutrição, dificultando o diagnóstico correto.
Suínos são particularmente sensíveis a essas toxinas, especialmente nas fases de creche, crescimento, gestação e lactação, quando a exigência nutricional e a vulnerabilidade imunológica são maiores.
O clima tropical do Brasil favorece o crescimento de fungos em todas as etapas da cadeia, no campo, na colheita, no transporte e no armazenamento.
Por isso, controlar a qualidade dos ingredientes desde a origem é essencial. A adoção de boas práticas de armazenagem, como secagem adequada dos grãos e controle da umidade, é uma das principais formas de prevenção.
Atualmente, já são conhecidos mais de 400 tipos de micotoxinas, o que torna seu controle bastante desafiador.
Como os tratamentos após a ingestão nem sempre são eficazes, a melhor estratégia continua sendo a prevenção. Isso inclui o monitoramento constante da matéria-prima, escolha criteriosa de fornecedores e uso regular de tecnologias de controle como os adsorventes.
Com isso, é possível reduzir perdas econômicas, proteger o desempenho dos animais e garantir a segurança dos alimentos produzidos.
MICOTOXINAS NA PRODUÇÃO DE SUÍNOS
Aflatoxinas
As aflatoxinas (AFs) são micotoxinas produzidas principalmente pelos fungos Aspergillus flavus e Aspergillus parasiticus, com destaque para a aflatoxina B1 (AFB1), considerada a mais tóxica e preocupante do grupo.
Essa substância apresenta elevada hepatotoxicidade, podendo comprometer severamente o fígado dos suínos, além de exercer efeitos imunossupressores, reduzindo a resposta do sistema imune, e propriedades carcinogênicas.
Em suínos, a exposição contínua mesmo a baixos níveis de AFB1 pode levar à queda no desempenho zootécnico, maior incidência de doenças infecciosas e prejuízos reprodutivos, sendo especialmente preocupante em fases críticas como crescimento e reprodução.
A dose letal média (DL₅₀) da AFB1 em suínos varia entre 0,5 e 0,6 mg/kg de peso corporal, havendo relatos de contaminações até 850 vezes superiores ao limite legal de 50 µg/kg nas rações (Zain, 2023; Mallmann et al., 1994).

Os sinais clínicos variam conforme a dose e tempo de exposição. Em casos agudos, observam-se tremores, diarreia hemorrágica e morte súbita em até 24 horas; em exposições moderadas, surgem icterícia, emagrecimento e queda no desempenho zootécnico (Santurio, 2007).
As lesões hepáticas incluem necrose, cirrose e edema da vesícula biliar (Mallmann et al., 1994).
Zearalenona
Após ser ingerida, a aflatoxina B1 (AFB1) é rapidamente absorvida no intestino dos suínos e levada até o fígado, onde passa por um processo de transformação por enzimas do sistema citocromo P450.
Durante esse processo, são formados diferentes metabólitos, como a aflatoxina M1 que pode ser eliminada pelo leite de fêmeas lactantes, a aflatoxicol que funciona como uma forma de armazenamento no fígado e o epóxido AFB1-8,9, que é altamente tóxico.
Esse último é o responsável pelos efeitos mais graves, pois se liga ao DNA das células, prejudica a produção de proteínas essenciais e pode causar alterações genéticas e até câncer. (Wu et al., 2022).
A zearalenona (ZEN) é uma micotoxina produzida por fungos do gênero Fusarium, como Fusarium graminearum e Fusarium culmorum.
Seu principal efeito nos animais está relacionado à sua ação estrogênica, já que essa toxina imita o hormônio estradiol. Isso faz com que interfira diretamente no sistema reprodutivo, sendo especialmente prejudicial para suínos, que são bastante sensíveis à ZEN.
Em leitoas, a exposição à zearalenona pode causar um quadro de hiperestrogenismo, levando a sinais como inchaço da vulva, prolapso retal, inflamação da vulva e vagina, pseudogestação, atrofia dos ovários e até deformidades como “splay-leg” em leitões ao nascimento (Edwards et al., 1987; Gajęcka, 2014).

Já em fêmeas adultas, a ZEN altera o ciclo reprodutivo, podendo causar retorno tardio ao cio, perda embrionária e queda na taxa de concepção.
Quando presente na dieta em níveis superiores a 3 ppm, a micotoxina pode provocar anestro funcional (ausência de cio), e em concentrações de 4 ppm, pode reduzir o peso ao nascer dos leitões em até 24% (Etienne & Jemmali, 1982; Santurio, 2007).
A exposição aguda ao DON, pode causar vômitos, perda de apetite e fraqueza nos suínos. Quando a exposição é prolongada e em níveis menores, ocorre uma redução no consumo de ração e no ganho de peso, além do enfraquecimento do sistema imunológico (Rotter et al., 1996; Pestka, 2007).

Isso acontece porque o DON provoca danos no intestino, como a atrofia das vilosidades intestinais (que são estruturas responsáveis pela absorção de nutrientes), morte programada das células intestinais (apoptose) e aumento da permeabilidade da parede intestinal, facilitando a entrada de agentes nocivos no organismo.
A exposição crônica compromete a função uterina e endometrial, prolonga a atividade do corpo lúteo e pode causar abortos e natimortos. Leitões expostos ao leite contaminado apresentam atraso no crescimento e alterações genitais.
Mesmo exposições leves (1,5–2 ppm) impactam leitoas pré-púberes (Etienne e Dourmad, 1994). Em machos, há feminilização, redução de libido, queda da testosterona e atrofia testicular (Gajęcka, 2014). Além disso, a ZEN também compromete a imunidade e a regeneração tecidual (Marin et al., 2011).
Desoxinivalenol
O desoxinivalenol (DON), ou vomitoxina, é uma tricotecena tipo B produzida por F. graminearum e F. culmorum, sendo a mais prevalente dessa classe. É rapidamente absorvido no intestino delgado e excretado via urina (Prelusky et al., 1988; Döll et al., 2004).
Além disso, a toxina prejudica a ação de receptores e moléculas importantes para a defesa do organismo, como os receptores Toll-like (TLRs) e as citocinas, que são essenciais para uma resposta imune eficiente (Pinton e Oswald, 2014; Gerez et al., 2015).
Os efeitos do DON podem ser ainda mais severos quando essa micotoxina está presente junto com outras, como a zearalenona (ZEN) ou o nivalenol (Cano et al., 2013).
Fumonisinas
Esta é a principal micotoxina deste grupo que afeta principalmente suínos e aves. A fumonisina B1 é o metabólito mais abundante desse grupo de micotoxinas, representando cerca de 70% nos alimentos naturalmente contaminados. As fumonisinas B2 e B3 ocorrem em concentrações menores (Shephard et al., 1996).

Os suínos têm alta sensibilidade às fumonisinas, tolerando apenas concentrações abaixo de 10 mg/ kg de alimento. Essa constatação foi observada em diversos surtos naturais e experimentais (Haschek et al., 1992).
Nos suínos, os principais órgãos-alvo são os pulmões, o fígado e o coração, e a síndrome específica nessa espécie é o edema pulmonar suíno, geralmente acompanhado de hidrotórax (Osweiler et al., 1992; Smith et al., 2000).
As fumonisinas, especialmente a fumonisina B1 (FB1), são produzidas por Fusarium verticillioides e inibem a ceramida sintase, afetando a biossíntese de esfingolipídios, essenciais à integridade celular, principalmente nos sistemas nervoso e respiratório (Santurio, 2007; Riley et al., 2019).
Essa alteração é causada pela ingestão de doses elevadas da micotoxina por curtos períodos. Os maiores danos, no entanto, são decorrentes da ingestão de doses baixas da toxina, que induzem lesões hepáticas e hiperplásicas na mucosa esofágica em leitões desmamados (Casteel et al., 1993). Nesses casos, observa-se principalmente a redução do ganho de peso nos suínos.
TRATAMENTO, PREVENÇÃO E DESAFIOS
O tratamento das intoxicações por micotoxinas é um grande desafio na produção animal. A primeira e mais importante medida é remover imediatamente a ração contaminada para evitar a continuidade da exposição.
O tratamento de suporte, que pode incluir cuidados para aliviar os sintomas e fortalecer os animais, pode ajudar a melhorar ligeiramente a recuperação, mas não elimina os efeitos das toxinas.
Alguns veterinários utilizam a suplementação com aminoácidos sulfurados na tentativa de ajudar na recuperação do fígado e do metabolismo, porém ainda não há evidências científicas suficientes que comprovem a eficácia dessa prática.
Diante da baixa eficiência terapêutica, a prevenção continua sendo a estratégia mais eficaz e economicamente viável no combate às micotoxinas.
Medidas profiláticas envolvem desde práticas agrícolas adequadas, como a colheita logo após a maturidade fisiológica dos grãos, até a secagem e o armazenamento corretos, evitando condições que favoreçam o crescimento de fungos.

Além disso, o uso de ácidos orgânicos e adsorventes naturais ou modificados mostra-se promissor em situações de campo, embora ainda requeira mais estudos científicos.
A detecção de fungos e toxinas por meio de amostragem e testes bioquímicos é fundamental para garantir a segurança dos alimentos e estabelecer limites de aceitabilidade para comercialização.
Uma alternativa prática e eficiente para minimizar os efeitos tóxicos das micotoxinas nas dietas é a utilização de aditivos antimicotoxinas (AAM), que são compostos inertes capazes de se ligar de forma irreversível às micotoxinas no trato gastrointestinal, impedindo sua absorção e favorecendo a excreção pelas fezes (Fávero, 2008).
Dentre os mais utilizados estão as argilas purificadas, como as bentonitas e zeólitas, bastante aplicadas na nutrição de aves e suínos como estratégia para reduzir os efeitos tóxicos dessas substâncias (Mallmann et al., 2006).
Esses adsorventes atuam principalmente por mecanismos físicos e químicos, formando complexos com determinadas micotoxinas, especialmente as aflatoxinas.
Estudos demonstram que frações da parede celular de leveduras, como os mananoligossacarídeos, têm boa capacidade de ligação a micotoxinas.
Em suínos, a inclusão de AAM à base de glucanos modificados mostrou efeitos positivos na recuperação do apetite, crescimento e redução da mortalidade em fases críticas como a recria (Edwards, 2002).
Para ser eficiente, um bom AAM deve apresentar: ampla capacidade de adsorção, estabilidade térmica, baixa interação com nutrientes, eficácia em diferentes faixas de pH e boa dispersão na ração. Além disso, deve ser seguro e economicamente viável.
Micotoxinas em suínos: impactos zootécnicos e abordagens de controle BAIXAR EM PDF



EFEITO DA SUPLEMENTAÇÃO COM PEPTASANTM SOBRE O DESEMPENHO E A SAÚDE INTESTINAL EM FRANGOS DESAFIADOS COM EIMERIA SPP.
Sol C¹, Villalobos G¹, Horta F¹, López R¹²*, Lee J³ e Kim W K³ ¹ Nuproxa Suíça, Vaud, Suíça. ²Nuproxa México, Querétaro, México.
³ Departamento de Ciências Avícolas, Universidade da Geórgia, Athens, GA, EUA. roberto.lopez@nuproxa.mx
INTRODUÇÃO
As crescentes preocupações com o uso de medicamentos, aditivos sintéticos e resistência microbiana na produção avícola têm aumentado o interesse por suplementos fitogênicos. Este estudo foi realizado para investigar os efeitos da suplementação com um produto poliherbal à base de Acacia concinna, entre outras plantas (PeptaSan™, Nuproxa, Suíça), sobre o desempenho, o estado de saúde intestinal e o grau de infecção em frangos de corte desafiados com Eimeria spp.
MATERIAL E MÉTODOS
Um total de 288 frangos de corte Cobb 500 machos de um dia de idade foram distribuídos aleatoriamente em 3 tratamentos, com 8 repetições por tratamento e 12 aves por gaiola, durante 28 dias.
Os tratamentos foram:
Controle Negativo, NC (dieta basal, não desafiada),
Controle Positivo, PC (dieta basal desafiada com inoculação de Eimeria spp.) e
PC + 500 ppm PeptaSan™ (PS).
As aves dos grupos PC e PS foram inoculadas com 62.500 oocistos de E. acervulina, 12.500 oocistos de E. maxima e 12.500 oocistos de E. tenella no dia 14.
Enquanto o grupo NC recebeu, por via oral, a mesma quantidade de PBS.
Os dados foram analisados estatisticamente utilizando o software JMP 16.0 (SAS Institute Inc., Cary, NC).
As médias dos tratamentos foram comparadas pelo teste de Tukey HSD. As pontuações de lesões foram analisadas pelo teste do Qui-quadrado de Pearson para identificar diferenças significativas entre os tratamentos. A significância estatística foi considerada para P<0,05, sendo indicada significância elevada para P<0,001.
RESULTADOS
Os resultados de desempenho mostraram que aos 28 dias, as aves do grupo PS foram
as mais pesadas (1648a, 1495b e 1704a gramas para NC, PC e PS, respectivamente, P=0,0002), com menor conversão alimentar (1,40b, 1,45a e 1,39b para NC, PC e PS, respectivamente, P=0,0014) e
menor mortalidade (1,04%, 2,08% e 0,00%, respectivamente).
O grupo PS apresentou uma redução significativa na excreção de oocistos (P<0,05) de
E. tenella aos 6-7-8-9 dias após a inoculação (DPI),
E. maxima aos 7 e 9 DPI e
E. acervulina aos 6 DPI (P=0,055).
Além disso, a suplementação com PS reduziu (P<0,0001) as pontuações de incidência de lesões graves no duodeno (0,00c, 2,63a, 2,00b) e no ceco (0,00c, 2,13a, 1,38b) para NC, PC e PS.
Quanto à expressão gênica, o desafio com Eimeria spp. aumentou (P<0,05) a expressão de:
claudina 1 (CLDN-1) e citocinas pró-inflamatórias: interleucinas IL-1β, IL-6, TNF-α e IFN-γ no jejuno do grupo PC;
em contraste, no grupo PS, a expressão gênica de CLDN-1, IL-1β e
TNF-α no jejuno foi reduzida (P<0,0001), com aumento numérico da enzima glutationa peroxidase (GPX) em comparação ao grupo PC.
CONCLUSÕES
A suplementação com 500 ppm do produto herbal mitigou os efeitos negativos causados pelo desafio com Eimeria spp.
IMPLICAÇÕES
Sugere-se que o produto herbal pode ser uma ferramenta dietética eficaz para melhorar o desempenho e a saúde intestinal de frangos desafiados com Eimeria spp.

Efeito da suplementação com Peptasantm sobre o desempenho e a saúde intestinal em frangos desafiados com Eimeria spp. BAIXE EM PDF
PONTOS-CHAVE PARA GARANTIR O SUCESSO NUTRIÇÃO DE BEZERRAS: DA FUTURA LEITEIRA (PARTE I)
José Luis Repetto, Germán Antúnez e Cecilia Cajarville Departamento de Produção Animal e Saúde nos Sistemas Produtivos. Faculdade de Veterinária, Universidade da República.
Acria e recria de bezerras leiteiras é um processo fundamental para garantir o futuro produtivo do rebanho. O objetivo principal é conseguir um desenvolvimento adequado do corpo e do tecido mamário, o que permitirá às novilhas expressar o seu potencial de produção na idade adulta. Este processo divide-se em várias etapas, que estão esquematizadas na Figura 1.



Nascimento

Figura 1. Esquema das diferentes fases da criação e recriação de bezerras leiteiras, onde se representa o nascimento (momento em que o colostro é fundamental), o desmame (aproximadamente aos 2 meses de idade), a puberdade (que ocorre aproximadamente aos 10 meses, quando a bezerra atinge 40-45% do seu peso vivo adulto (PVa)), o momento ideal para a primeira cobertura (por volta dos 15 meses, quando a bezerra atinge 55% do seu PVa). Todo esse processo permitirá que o primeiro nascimento chegue aos 2 anos de idade com peso ideal (85% do PVa).
Digestão nas primeiras fases da vida
Os filhotes de ruminantes nascem com préestômagos de tamanho reduzido e carecem de microrganismos suficientes capazes de degradar fibras vegetais, o que os impede de obter energia através da fermentação microbiana no trato digestivo.
Por esse motivo, durante as primeiras 3 a 4 semanas de vida, os processos digestivos dos pré-ruminantes são semelhantes aos de um monogástrico, dependendo principalmente de enzimas digestivas próprias que atuam no abomaso e no intestino para processar os nutrientes.



Figura 2. Desenvolvimento esquemático do sistema digestivo dos ruminantes na primeira semana de vida (A), aos 3-4 meses (B) e na maturidade (C). Na primeira semana de vida, o rúmen representa 25% da capacidade total do trato digestivo, enquanto na maturidade chega a 80%. O contrário acontece com o abomaso, que na primeira semana de vida representa 60% da capacidade digestiva total e, em bovinos adultos, não ultrapassa 8% (extraído de Jones e Heinrichs, https://extension.psu.edu/feeding-the-newborn-dairy-calf#section-27)

Nesta fase, as enzimas digestivas são limitadas em quantidade e variedade, mas são suficientes para digerir os principais componentes do colostro e do leite, como caseína, lactoglobulinas, triglicerídeos e lactose, que constituem os alimentos naturais dos filhotes durante as primeiras semanas de vida. À medida que a dieta se diversifica, o espectro de enzimas digestivas se amplia, adaptandose aos novos substratos.
A digestão das proteínas é muito reduzida durante as primeiras 24 a 48 horas de vida (Guilloteau et al., 1995), o que permite que as imunoglobulinas (Ig) presentes no colostro passem para a corrente sanguínea, proporcionando níveis adequados de imunidade para esta fase crítica.
O trato digestivo dos ruminantes tem uma disponibilidade muito restrita de enzimas até aproximadamente 21 dias de idade. O complexo enzimático do recém-nascido é composto por uma enzima proteolítica com atividade (a quimosina), lipases pré-gástricas e pancreáticas (embora esta última tenha uma atividade fraca no início) e a lactase, que é a enzima glicolítica responsável pela digestão da lactose, o principal carboidrato do leite.
Nesta fase, as maltases (que digerem hidratos de carbono de cadeia curta) são incipientes e as amilases (que permitem digerir o amido) ainda não estão presentes (Figura 3). Com este pacote enzimático inicial, os ruminantes são capazes de digerir os nutrientes do leite, mas não muito mais.


Ao longo dos primeiros dias, os ruminantes desenvolvem gradualmente o seu conjunto enzimático, tornando-se capazes de digerir adequadamente proteínas e lipídios. No entanto, até aproximadamente 3 semanas de vida, a secreção de enzimas capazes de degradar amidos e outros hidratos de carbono diferentes da lactose é escassa.
Portanto, é essencial que ao utilizar substitutos do leite desde o início da vida (após o desmame), eles atendam às seguintes condições:
A fonte de proteína deve ser de origem láctea ou plasma animal e, se forem utilizadas fontes vegetais, estas devem ser corretamente hidrolisadas e incluídas em proporções baixas.
Não contenham amido. A principal fonte de carboidratos é a lactose, que normalmente compõe 45% do substituto.
Os lípidos, gorduras ou óleos devem ser emulsionados para que possam ficar em suspensão no líquido.
Os insumos devem provir principalmente do leite ou ter recebido um tratamento específico que garanta uma digestão correta por parte das bezerras.

Glândula salivar
Lipase pré-gástrica
Coágulo de leite
Pâncreas
Lactase
Maltase
Figura 3. Enzimas digestivas secretadas pelo pré-ruminante para o lúmen do trato digestivo (extraído de Garin et al., 2003)
Uma lactação adequada é fundamental
O colostro é a primeira fonte de nutrientes e anticorpos para as bezerras. É fundamental que as bezerras ingiram colostro nas primeiras 24 horas de vida. Lembremos que o tipo de placenta dos bovinos (epiteliocorial) impede a passagem de macromoléculas, pelo que se trata de uma espécie praticamente agamaglobulinémica ao nascer, necessitando da ingestão e absorção de colostro rico em anticorpos e outros fatores imunitários que proporcionam imunidade passiva.

Recomenda-se que as bezerras consumam entre 150-200 g de IgG (imunoglobulina G) neste período (NASEM, 2021). Para isso, devemos ter em conta que nem todos os calostros são iguais e que a concentração de IgG pode variar muito.
Intestino Grosso

Num estudo realizado nos Estados Unidos, Heinrichs et al. (2020) observaram uma enorme variação entre o colostro e a contaminação por E. Coli em mais de 50% dos colostros analisados. É por isso que, em geral, observa-se que após a pasteurização melhora a absorção de Ig. Na verdade, o tratamento térmico não provoca a melhoria por si só, mas elimina a carga microbiana que interfere na absorção das Ig.
Por outro lado, estudos demonstraram que o colostro não só proporciona imunidade, mas também contém muitas e diversas proteínas (mais de 62), é rico em energia, peptídeos bioativos, hormônios e fatores de crescimento (relaxina, insulina, IGF1, IGF2, etc.) que favorecem o desenvolvimento digestivo e geral do bezerro (Kargar et al., 2020).
Por que o crescimento é importante?
Em todos os animais (incluindo os humanos), é sabido que o crescimento nas primeiras fases da vida é fundamental para o desempenho futuro, e as bezerras leiteiras não são exceção.
Nas bezerras, um maior crescimento nas primeiras semanas de vida está associado a um maior desenvolvimento do tecido mamário e a uma maior produção de leite na primeira lactação (Brown et al., 2005). Parece que esses efeitos positivos na produção de leite são observados a partir de ganhos de peso de 0,5 kg/dia (Gelsinger et al., 2016).
Partindo do conceito de que a nutrição nas primeiras fases é fundamental e que, tradicionalmente, as bezerras leiteiras criadas separadas das mães ingerem menos leite do que ingeririam se estivessem ao pé das mães, surgiu, há alguns anos, o conceito de criação acelerada de bezerras.

Por isso, o fornecimento de colostro até 72 horas após o nascimento do bezerro favorece o crescimento e a maturação das vilosidades intestinais, o que será muito útil no momento da transição, quando ele enfrentará o desafio da passagem de préruminante para ruminante.
Além disso, após o colostro, atualmente enfatiza-se a recomendação de fornecer leite de transição durante os primeiros 3-4 dias de vida. Este leite, produzido dias após o colostro, favorece o desenvolvimento intestinal, aumenta o tamanho das vilosidades e melhora a saúde geral das bezerras (Van Soest et al., 2022).
Basicamente, a criação acelerada procura duplicar o peso das bezerras aos 60 dias de vida, fornecendo mais alimento lácteo (até o dobro) em comparação com a criação tradicional (Drackley, 2008; Kertz et al., 2017). Esta abordagem demonstrou melhorar o crescimento e o desenvolvimento das bezerras, embora também possa reduzir o consumo de concentrado durante a fase de lactação (Gelsinger et al., 2016).



O tema da criação acelerada de bezerras, suas possíveis vantagens e desvantagens, será abordado na parte II desta publicação. Agora vamos nos concentrar em aspectos gerais de como a dieta e o crescimento afetam o desenvolvimento das bezerras como futuras vacas leiteiras.
Um receio que tradicionalmente assombra os produtores de leite e os técnicos em leite é que, se alimentarmos muito bem as novilhas, podemos provocar um menor desenvolvimento mamário devido ao acúmulo de tecido adiposo na glândula, o que, evidentemente, prejudicará a produção de leite.
Figura 4. Relação entre proteína metabolizável (PM) e energia metabolizável (EM) necessária para o crescimento adequado de bezerras leiteiras, de acordo com a NASEM (2021). As diferentes curvas correspondem a diferentes pesos de vacas adultas (500, 600, 700 ou 800 kg de peso vivo (PV) adulto). Note-se que quanto maior for o peso estimado do adulto e mais jovem (com menor peso) for a novilha, maior deverá ser a proporção de proteína na dieta.
Há evidências que permitem supor, no entanto, que o acúmulo de tecido adiposo em torno da glândula mamária esteja associada à relação entre energia e proteína na dieta, mais do que à densidade energética ou aos ganhos diários de PV.
É muito importante, quando se trata de bezerras que esperamos que tenham um desenvolvimento mamário ideal para produzir todo o seu potencial quando adultas, que a dieta não seja deficiente em proteínas. Lembremos que uma bezerra leiteira não deve engordar, mas sim desenvolver-se adequadamente e crescer em altura.
É importante, portanto, que não falte proteína na dieta e que não haja excesso de energia. O novo NASEM (2021) propõe que a relação entre proteína metabolizável (PM) e energia metabolizável (EM) da dieta dependerá do peso vivo do bezerro e da sua relação com o peso adulto. Assim, vacas de biotipos grandes e mais jovens precisarão de mais gramas de PM por Mcal de EM (figura 4).

Também é importante recorrer ao conhecimento básico quando se trata de alimentar as nossas novilhas. E, neste caso, podemos recorrer à fisiologia do crescimento dos animais.
Todos os animais passam por diferentes fases durante o crescimento. Esquematicamente, denomina-se fase de crescimento "isométrico" um crescimento em que todas as partes do corpo crescem na mesma proporção. Ou seja, não há alterações nas proporções corporais.
Enquanto isso, crescimento alométrico refere-se a um crescimento em que diferentes partes do corpo crescem a taxas diferentes, resultando em alterações nas proporções corporais.
No caso das bezerras leiteiras, a algumas décadas foi descrito que o crescimento da glândula mamária desde o nascimento até ao primeiro parto pode ser dividido em quatro fases:
Uma fase inicial de crescimento isométrico entre o nascimento e os 2-3 meses de vida.
Uma fase de crescimento alométrico que se estende até a puberdade (desde o desmame até os 9-10 meses).
Uma nova fase isométrica até ao último terço da gestação (19-20 meses de vida)
Uma nova fase de crescimento alométrico dos 20 meses até ao parto (Sinha e Tucker, 1969).
Durante as fases de crescimento alométrico, especialmente entre o desmame e a puberdade, o tecido mamário está em plena expansão. O parênquima mamário (tecido secretor de leite) está em desenvolvimento e é muito sensível à dieta. Além disso, na fase pré-puberal, hormônios como o IGF-1 (fator de crescimento insulínico tipo 1) e os estrogênios desempenham um papel fundamental no desenvolvimento mamário.
Esses hormônios são influenciados pela nutrição, especialmente pela ingestão de proteínas e energia. É por isso que, nesta fase é especialmente importante cuidar da relação proteína/energia na dieta.
Se houver um desequilíbrio a favor da energia (ou se faltar proteína na dieta), corremos o risco de que o teto fique gorduroso e a proporção de tecido secretor seja menor.
A transição de pré-ruminante
para ruminante: momento crucial na vida do bezerro
Historicamente, os alimentos sólidos eram formulados apenas com o objetivo de substituir os laticínios (alimentos caros) e, assim, poder retirá-los rapidamente, para fornecer alimentos mais baratos. Com o novo paradigma de alimentar da melhor forma possível os ruminantes para otimizar o crescimento e proporcionar-lhes uma vida produtiva melhor, o desafio de formular um concentrado que favoreça a transição torna-se mais importante. 1 2 3 4
Um dos objetivos fundamentais na criação de bezerras é favorecer a transição da lactação para a ruminação. Para isso, o consumo progressivo de sólidos é fundamental. No entanto, o conceito sobre o sólido que acompanha o leite está mudando.
manejo

Perdas por Salmonella custam caro.
O blend de ácidos orgânicos e óleos essenciais microencapsulados da Jefo é a solução.
Resultados comprovados Pesquisas científicas, de campo e aplicações comerciais
Tecnologia Jefo Matrix Microencapsulação original, exclusiva e patenteada
Saúde intestinal Prevenção e controle da Salmonella
Saiba mais:
jefo.com

leite l/d

concentrado kg MS/d
leite (Mcal EM/d)
4 litros 8 litros concentrado (Mcal EM/d) Mcal EM/d
Figura 5. Consumo de leite e concentrado em bezerras Holstein sob um sistema de criação tradicional (4 litros, barras azuis) e de criação acelerada (8 litros, barras vermelhas) (De Trinidad et al., 2014). Observe-se que as bezerras criadas tradicionalmente, ao consumirem menos leite, consomem mais concentrado e, portanto, a ingestão de energia proveniente do concentrado é maior nas bezerras criadas sob um sistema tradicional. No entanto, quando se calcula a ingestão energética total, verifica-se que o leite representa sempre a maior parte da ingestão energética. Neste trabalho, o leite representou 86% da energia metabolizável (EM) ingerida nas bezerras criadas de forma acelerada, enquanto nas bezerras criadas tradicionalmente representou 73% da EM ingerida. Em ambos os casos, a maior ingestão de energia foi através do leite.
Devemos ter em conta que, durante a fase de lactação, independentemente do sistema de criação que seguimos (acelerado ou tradicional), o leite ou substituto representa a principal fonte de energia das bezerras. Isso é exemplificado na Figura 5 , proveniente de um trabalho que compara a criação tradicional com a criação acelerada.
Com este panorama, fica claro que devemos promover o desenvolvimento de um rúmen funcional na futura vaca. O que isso implica?
Podemos resumir em três pontos:
1 2 3
Promover o desenvolvimento do tamanho do órgão
Promover o desenvolvimento papilar
Promover o desenvolvimento de uma microbiota diversificada e ativa, capaz de fermentar carboidratos complexos.
Sabemos que a ingestão de concentrado de iniciação é essencial para o desenvolvimento de um rúmen funcional e que alguns produtos da fermentação ruminal, como o butirato, são os principais responsáveis pelo desenvolvimento do epitélio ruminal.
No entanto, como veremos na próxima edição, não devemos esquecer a forragem. Estudos demonstraram que as bezerras que consomem forragem têm um ambiente ruminal mais favorável, com maior diversidade microbiana e um pH mais próximo do neutro.
Além disso, a forragem grosseira promove o consumo de concentrados e melhora o bem-estar das bezerras (Castells et al., 2013, Antúnez et al., 2024).

Em resumo
O investimento na criação e recriação de bezerras leiteiras é fundamental para garantir o sucesso futuro do rebanho.
Uma nutrição adequada nas primeiras fases da vida, incluindo uma boa lactação, uma transição eficaz para a ruminação e um crescimento ideal, permitirá que as bezerras expressem o seu máximo potencial produtivo na idade adulta.
Referências disponíveis na versão web do artigo em nutrinews.com
Nutrição das bezerras: Chaves para garantir o sucesso da futura leiteira (Parte I) BAIXAR EM
NAVEGANDO NO LABIRINTO DAS MICOTOXINAS COM O MYCO’KINGDOM

As micotoxinas são compostos tóxicos produzidos por certos tipos de fungos, que estão naturalmente presentes em matérias-primas agrícolas no mundo todo. Essas toxinas representam uma ameaça significativa à saúde e ao desempenho dos animais, impactando diretamente a produtividade e a rentabilidade das cadeias de produção animal.
Apesar dos avanços nas práticas agrícolas e nas tecnologias de processamento de rações, as micotoxinas continuam sendo um desafio persistente - principalmente devido à sua variabilidade, presença generalizada e interações complexas com a matriz da ração e a fisiologia dos animais.
Equipe Técnica OLMIX
Para mitigar de forma eficaz os efeitos negativos das micotoxinas, já não basta adotar medidas isoladas ou reativas. Hoje, é essencial uma estratégia holística, preventiva e orientada por dados. Esse é o objetivo da criação do Myco’Kingdom, uma nova plataforma digital da Olmix que reúne um conjunto de ferramentas especializadas e recursos científicos para a gestão completa do risco de micotoxinas. A solução foi pensada para apoiar produtores, nutricionistas e profissionais da indústria de rações na compreensão, avaliação e controle dos riscos ao longo de toda a cadeia, do campo até o cocho.
COMPREENDENDO OS
FUNDAMENTOS: FUNGOS E MICOTOXINAS
Micotoxinas são metabólitos secundários produzidos por fungos em resposta a condições ambientais ou fisiológicas de estresse, como variações de temperatura, seca, danos mecânicos ou competição microbiana. Embora não ofereçam um benefício direto ao fungo, representam um sério risco para os animais que consomem alimentos contaminados.

O risco de contaminação varia conforme a espécie fúngica, o tipo de cultivo, a região climática, as práticas agrícolas e as condições de armazenamento. Por exemplo, o milho é mais suscetível à contaminação do que outros grãos como trigo ou cevada. Também há padrões regionais: o deoxinivalenol (DON) é mais comum em climas temperados (como no norte da Europa), enquanto as fumonisinas predominam em regiões tropicais e subtropicais.
A complexidade no manejo das micotoxinas está, sobretudo, na imprevisibilidade dos níveis de contaminação, que podem variar significativamente de ano para ano, mesmo em uma mesma localidade. Fatores como:
Variedade da planta
Saúde do solo
Rotação de culturas
Época da colheita
Condições de secagem

Os fungos produtores de micotoxinas são geralmente classificados em dois grupos. Fungos de campo: como as espécies do gênero Fusarium, que contaminam os cultivos ainda no campo. Fungos de armazenamento: como Aspergillus e Penicillium, que proliferam após a colheita, especialmente em condições quentes e úmidas.
influenciam diretamente essa variabilidade. Por isso, é fundamental adotar um enfoque preventivo e sistêmico.

O Myco’Essentials, disponível tanto em formato impresso quanto digital dentro da plataforma Myco’Kingdom, oferece uma base sólida sobre micotoxinas, com informações essenciais sobre o comportamento dos fungos, biossíntese das toxinas, gatilhos ambientais e tendências de contaminação.

Outro recurso educacional importante da plataforma é o aplicativo Myco’Simulator, que permite visualizar no celular a estrutura molecular das principais micotoxinas. Ao analisar características como tamanho molecular, polaridade, flexibilidade e grupos funcionais, o usuário entende melhor por que algumas micotoxinas apresentam toxicidades específicasconhecimento crucial na hora de definir estratégias de controle.
MICOTOXICOSE: SUTIL, MAS COM GRANDES IMPACTOS

O termo micotoxicose se refere aos efeitos tóxicos que as micotoxinas provocam nos animais. Esses efeitos podem ser agudos (após exposição curta a doses elevadas) ou subclínicos (resultantes de exposição prolongada a baixas concentrações).
Enquanto as formas agudas podem apresentar sintomas claros como falência orgânica ou morte, elas são raras em sistemas comerciais.
O verdadeiro desafio está na micotoxicose subclínica, que muitas vezes passa despercebida, mas afeta significativamente o crescimento, a reprodução, a imunidade e a produtividade geral dos animais. Os impactos incluem redução no consumo de ração, problemas intestinais, falhas reprodutivas, menor resposta vacinal e maior susceptibilidade a infecções.
Para acompanhar os avanços científicos sobre os efeitos das micotoxinas, o boletim informativo Myco’News (parte do Myco’Kingdom) compartilha descobertas em toxicologia, química analítica, avaliação de riscos e pesquisa veterinária. É uma fonte confiável para profissionais da indústria de nutrição animal que buscam se antecipar às ameaças emergentes.
GESTÃO DE RISCO NA FAZENDA: DETECTAR E AGIR COM ANTECEDÊNCIA
Em muitas fazendas, os problemas causados por micotoxinas só são percebidos após perdas de desempenho ou surgimento de sintomas clínicos.
Porém, a detecção precoce é essencial para evitar danos irreversíveis.
A ferramenta Myco’Evaluator, gratuita e disponível online, avalia a probabilidade de contaminação por micotoxinas com base em fatores específicos da propriedade, como origem dos cultivos, práticas de armazenamento, métodos de colheita e secagem, e sinais clínicos observados nos animais. Embora não substitua um exame laboratorial, essa avaliação inicial serve como guia para decidir se é necessário realizar análises químicas.
CONTROLE NAS FÁBRICAS DE RAÇÃO:
ESTRATÉGIA DE AMOSTRAGEM E TESTES INTELIGENTES

No setor de produção de rações, estabelecer um plano de monitoramento de micotoxinas é fundamental para o controle de qualidade e a confiança do cliente. Contudo, a tarefa se torna mais complexa diante do fenômeno da policontaminação - ou seja, a presença de várias micotoxinas simultâneas nos ingredientes.
Como testar diariamente todos os lotes para dezenas de micotoxinas não é viável, é necessário um protocolo racional de amostragem e análise. Nesse contexto, a ferramenta Myco’Screen, da plataforma Myco’Kingdom, oferece diretrizes para uma coleta de amostras representativa e eficiente, lembrando que até 80% dos erros analíticos têm origem na amostragem, não nos procedimentos laboratoriais.
INTERPRETAÇÃO DOS RESULTADOS: TRANSFORMAR DADOS EM AÇÃO

Obter os resultados do laboratório é apenas uma parte do processo. Saber interpretar corretamente esses dados é essencial para tomar decisões assertivas. É importante entender como os níveis de contaminação interagem com a espécie animal, o estágio de produção e o estado de saúde.

Por exemplo, leitões e vacas leiteiras de alta produção exigem limites mais rígidos do que aves adultas ou ruminantes em manutenção. Além disso, ajustes na formulaçãocomo a substituição de ingredientes ou alterações nas taxas de inclusão - podem reduzir significativamente a exposição dos animais.

O Myco’Screen também oferece acesso tanto a métodos rápidos (como tiras ELISA ou testes em microplacas) quanto a análises completas por LC-MS/MS, capazes de detectar mais de 45 micotoxinas em uma única amostra. Essa abordagem flexível permite aos fabricantes equilibrarem agilidade, custo e profundidade analítica.
Os relatórios personalizados do Myco’Screen, desenvolvidos por especialistas da Olmix, ajudam a interpretar os resultados laboratoriais e sugerem medidas práticas adaptadas a cada cenário de produção.

REDUZINDO A EXPOSIÇÃO
ANIMAL: ESTRATÉGIAS ALÉM
DOS ADSORVENTES
Aditivos de suporte à saúde: compostos que protegem órgãos como o fígado, fortalecem a integridade intestinal e reforçam os mecanismos antioxidantes, permitindo que os animais enfrentem melhor os efeitos residuais das toxinas. Mesmo com medidas preventivas eficazes, é praticamente impossível eliminar todas as micotoxinas da ração. Por isso, muitas formulações incluem estratégias de desativação, principalmente com:
Adsorventes: substâncias que se ligam às micotoxinas no trato digestivo, impedindo sua absorção (como bentonitas, argilas ativadas, paredes celulares de leveduras, sepiolita, entre outras).
Agentes biotransformadores: enzimas ou microrganismos que degradam ou modificam as micotoxinas em formas menos tóxicas.
UMA NOVA ERA NO CONTROLE DE MICOTOXINAS
A crescente complexidade da produção animal moderna exige soluções cada vez mais integradas e inteligentes. Com o Myco’Kingdom, a Olmix oferece aos profissionais da cadeia agroalimentar uma plataforma completa com dados, diagnósticos, recursos educacionais e suporte técnico especializado.
Ao integrar ferramentas de avaliação em tempo real, conteúdos científicos, diretrizes práticas e interpretações especializadas, o Myco’Kingdom promove a transição de uma abordagem reativa para uma prevenção estratégica e proativa. Seja na formulação de dietas, no controle de ingredientes ou na resolução de problemas produtivos, esta plataforma está pronta para apoiar cada etapa do processo.
MENSAGEM FINAL
Um adsorvente eficaz costuma ser uma combinação estratégica de múltiplos componentes, capaz de atuar sobre um amplo espectro de micotoxinas, inclusive as mais difíceis como DON e fumonisinas.
O Myco’Calculator, ferramenta incluída no Myco’Kingdom, auxilia na definição da dosagem ideal do adsorvente, considerando o perfil de contaminação, a espécie animal, o estado sanitário e os aspectos econômicos. Com isso, é possível otimizar o uso dos aditivos e garantir eficiência com bom custo-benefício.
As micotoxinas são um desafio inevitável, porém gerenciável, na nutrição animal. Com uma avaliação de risco antecipada, diagnósticos precisos, interpretação correta dos dados e intervenções bem planejadas — incluindo o uso de adsorventes —, fabricantes de ração, veterinários e produtores podem reduzir seu impacto e proteger a saúde e o desempenho dos animais.
O Myco’Kingdom da Olmix é uma plataforma completa, com ferramentas desenvolvidas para ajudar nutricionistas e formuladores a gerenciar os riscos por micotoxinas de forma eficaz e moderna.
Navegando no labirinto das micotoxinas com o Myco’Kingdom
BAIXAR EM PDF




Feito com bi-quelato.

Um
NOVUS
novusint.com/poultryminerals
SOMENTE MINTREX® MINERAIS ORGÂNICOS BI-QUELATADOS ENTREGAM A ABSORÇÃO PROATIVA QUE VOCÊ PRECISA PARA MAXIMIZAR A NUTRIÇÃO.
Nossos minerais orgânicos bi-quelatados são os únicos minerais que demonstraram que podem passar intactos pelo trato digestivo e chegar ao sítio de absorção, promovendo maior enriquecimento tecidual. Com uma biodisponibilidade mineral superior, MINTREX® minerais orgânicos bi-quelatados contribui com a redução da mortalidade e otimiza o crescimento de frangos de corte, melhorando sua integridade estrutural para que permaneçam mais saudáveis e apresentem um desempenho superior do início ao fim.
e MINTREX são marcas comerciais da Novus International, Inc. e estão registradas nos Estados Unidos e em outros países. ©2025 Novus International, Inc. Todos os direitos reservados.
Mineral Orgânico Bi-quelatado
produto